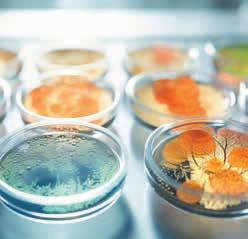

![]()





Datum: 14. listopadu 2025
Místo: PVA EXPO PRAHA 2025

Průmyslový Summit je jednodenní konference zaměřená na budoucnost českého i evropského průmyslu. Nabízí prostor, kde se potkávají inovace v oblasti umělé inteligence, pokročilé technologie a cenná obchodní data.


PROMO KÓD: časopis
SLEVA 35%




www.prumyslovysummit.cz



Jednodenní summit zaměřený na klíčové pilíře průmyslové transformace
STAGE 1
Energy & Innovation
Průmyslová výroba, energetika, digitalizace, AI, export

STAGE 2
Workshopy
HR strategie, talent, well-being, leadership, AI v náboru
Do jednoho místa přivádí lídry výrobních firem, technologické inženýry, odborníky na energetiku, logistiku a digitalizaci, stejně jako investory a strategické partnery. Cílem setkání je podpořit konkrétní spolupráci, otevřít nové obchodní příležitosti a inspirovat k rozvoji, který odpovídá aktuálním výzvám i budoucímu směřování průmyslu. Program probíhá ve dvou paralelních scénách. Jedna je zaměřena na technologie, automatizaci a využití umělé inteligence ve výrobě, druhá na vedení lidí, moderní přístupy v HR a digitální nástroje pro rozvoj týmů. Během jediného dne vystoupí více než třicet řečníků. Účast se očekává od více než tří set padesáti zástupců průmyslu. Program doplní případové studie, panelové diskuse a tematicky zaměřené rozhovory.


Summit navazuje na dlouhodobou práci redakce Světa průmyslu a jeho partnerů, kteří v průběhu let vytvořili rozsáhlou síť kontaktů a datovou základnu. Díky tomu dokáže propojit firmy i odborníky, kteří se v každodenním provozu často míjejí, a nabídnout prostor pro věcnou debatu i navázání nových spoluprací.

























26 –













VYDAVATELSTVÍ:
Smart Connections, s.r.o.
8. května 3253/28, 787 01 Šumperk
IČ: 27854647, DIČ: CZ27854647
Registrační číslo: MK ČR E 18823, ISSN: 1804-3925
Společnost je zapsána v obchodním rejstříku C 43508



vedená u Krajského soudu v Ostravě.









www.smart-connections.cz www.svetprumyslu.cz
VEDENÍ SPOLEČNOSTI:
Jednatel: Mgr. Lukáš Ševčík, sevcik@svetprumyslu.cz
Provozní ředitelka: Ing. Markéta Vondálová, vondalova@svetprumyslu.cz
OBCHODNÍ ODDĚLENÍ:
Obchodní ředitelka: Ing. Lucie Urbanová, urbanova@svetprumyslu.cz
Teamleader: Veronika Kučerová, kucerova@svetprumyslu.cz
Mediální konzultant: Vilém Dýčka, dycka@svetprumyslu.cz
Mediální konzultant: Jiří Veselý, vesely@svetprumyslu.cz
Podpora inzerce: Veronika Bartlová, bartlova@svetprumyslu.cz
GRAFICKÉ ODDĚLENÍ:
Grafika: Šárka Říhová, grafika@svetprumyslu.cz
Specialista pro sociální sítě a marketing: Eva Moudrá, moudra@svetprumyslu.cz
REDAKCE: redakce@svetprumyslu.cz
PERSONÁLNÍ A EKONOMICKÉ ODDĚLENÍ: Ing. Jitka Dokoupilová, dokoupilova@svetprumyslu.cz
DATUM VYDÁNÍ: 19. 9. 2025
ČÍSLO VYDÁNÍ: 4/2025
Cena jednotlivého výtisku: 289 Kč | 11,7 €
INZERCE:
Telefon: +420 775 221 606
E-mail: urbanova@svetprumyslu.cz
Tisk:
Printo, spol. s r.o. (zabek@printo.cz)
Předplatné:
Informace podává a objednávky přijímá vondalova@svetprumyslu.cz, vyřizuje společnost SEND Předplatné, spol. s r.o., Ve Žlíbku 1800/77, Hala A3, 193 00 Praha 9 – Horní Počernice.
Autorská práva vykonává vydavatel.
Copyright © 1996–2025. Publikování, přetištění či šíření obsahu nebo jeho částí jakýmkoli způsobem v českém či jiném jazyce bez předchozího písemného souhlasu vydavatele je zakázáno.
Publikace obsahuje ilustrační obrázky a fotografie Adobe Stock. Tyto obrázky jsou použity v souladu s licencí.






Syneriq a. s.
Jiří Kasner, předseda představenstva
strana 12 – 15
Konica Minolta Business Solutions Czech, spol. s r.o.
Aleš Fukal, ředitel divize Digital Information Management CZ/SK
„DATA JSOU TO NEJCENNĚJŠÍ, CO FIRMA MÁ. JENŽE DOKUD SE NIC NESTANE, BEZPEČNOST NIKDO NEŘEŠÍ.“
strana 18– 21









Manutan s.r.o.
Tomáš Martinek, obchodní ředitel CZ/SK
strana 28–29
Aitom Digital s.r.o.
Daniel Musil, Co-owner & RevOps Evangelist
„ZÁKAZNÍCI SE ČASTO OTEVŘOU SPÍŠE TŘETÍ STRANĚ NEŽ SVÉMU DODAVATELI. EXTERNÍ FACILITÁTOR DOKÁŽE ZPĚTNOU VAZBU PŘEVÉST DO KONKRÉTNÍCH DOPORUČENÍ.“

strana 46 – 47 „BEZPEČNOST NELZE KOUPIT JAKO SLUŽBU. MUSÍ BÝT SOUČÁSTÍ NÁVRHU OD SAMÉHO ZAČÁTKU A BEZ LIDÍ, KTEŘÍ SYSTÉMU ROZUMÍ, NIKDY NEBUDE FUNGOVAT SPRÁVNĚ.“ „VĚTŠINU VÝROBKŮ PRIVÁTNÍ ZNAČKY SI NECHÁVÁME VYRÁBĚT V EVROPĚ CO NEJŠETRNĚJŠÍMI POSTUPY. ZKRACUJEME TÍM PŘEPRAVNÍ TRASY, PODPORUJEME LOKÁLNÍ VÝROBCE A SNIŽUJEME UHLÍKOVOU STOPU.“




Konecranes and Demag s.r.o.
Lukáš Rosenberg, Sales Manager Czech CZ/SK
„POKUD CHCE MÍT MAJITEL KLIDNÉ SPANÍ A SPOLEHLIVOU VÝROBU, DOKÁŽEME PŘEVZÍT ZODPOVĚDNOST ZA JEHO JEŘÁBOVÝ PARK A RUČÍME ZA PLNĚNÍ ZÁKONA I SPOLEHLIVÝ PROVOZ.“
strana 82 – 83

Češi vytiskli první 3D dům v Lucembursku
Česká společnost ICE Industrial Services ze Žďáru nad Sázavou slavnostně otevřela v obci Niederanven první 3D tištěný dům v Lucembursku. Stavba o velikosti 2+kk a rozloze 47 m² byla vytištěna z minerálních materiálů během jednoho měsíce, celkový proces včetně administrativy trval deset týdnů. Cena projektu dosáhla přibližně 320 tisíc eur, tedy osm milionů korun.
Dům je navržen jako startovací bydlení pro mladé páry. Je vybaven solárními panely a deseti bateriovými úložišti, což mu zajišťuje vysokou energetickou soběstačnost. Stěny mají integrované dutiny pro izolaci i připravené prostupy pro instalace, což výrazně zkracuje dobu výstavby a snižuje potřebu dodatečných úprav.
Projekt reaguje na bytovou krizi v Lucembursku, kde ročně chybí zhruba tři tisíce domů. Technologie 3D tisku umožňuje využít i menší nebo nepravidelné pozemky, které pro klasickou výstavbu nejsou vhodné. O pilotní dům projevilo zájem více než dvacet uchazečů a podle zástupců lucemburské strany by mohlo následovat až 40 dalších jednotek.
Na projektu spolupracoval architekt Bujar Hasani (Coral 3DCP Architecture) a stavitel Georgios Staikos. Pilotní dům se tak stal ukázkou, jak může
česká technologie nabídnout řešení pro dostupnější a udržitelnější bydlení v Evropě.
Výpočetní centra soustředěná do několika lokalit kladou na síť jiný typ zátěže než těžba kryptoměn. Tlak na nové výrobní kapacity vede v některých případech i k návratu k fosilním zdrojům nebo jádru. Dekarbonizace zůstává prioritou, podle Mezinárodní energetické agentury by se podíl obnovitelných zdrojů měl v datových centrech do roku 2030 zvýšit z 27 na 50 %.
Otázka však zní: dokáže energetika držet krok s rychlostí rozvoje AI?

Česká republika má pevné datum konce těžby uhlí: Důl Bílina skončí v roce 2033
Těžba hnědého uhlí v severočeském dole Bílina skončí nejpozději k 31. prosinci 2033. Rozhodnutí potvrdil Český báňský úřad, který tak stanovil konečný termín ukončení provozu posledního aktivního hnědouhelného dolu v zemi. Společnost Severočeské doly ze skupiny ČEZ sama navrhla ukončení těžby dříve, než původně plánovala.
Po roce 2033 budou v lokalitě probíhat rozsáhlé sanační a rekultivační práce. Ty musí být prováděny podle pevného harmonogramu a ve spolupráci s odborníky i místními obcemi, aby krajina získala novou funkci a ekologickou hodnotu.
Stanovení jasného data je zásadním signálem pro českou energetickou transformaci. Podle environmentálních organizací jde o potvrzení závazku státu směřovat k nízkoemisním zdrojům. Zároveň rozhodnutí otevírá diskusi o sociální a ekonomické budoucnosti regionu, který byl po desetiletí závislý na těžbě uhlí.

STEM revoluce v Bulharsku: školy získají moderní laboratoře i nové učební osnovy
Bulharsko se pustilo do jednoho z nejambicióznějších vzdělávacích projektů v Evropě. Do léta 2026 mají být všechna z 2 300 škol vybavena STEM laboratořemi, které zásadně promění způsob výuky vědy, technologií, inženýrství a matematiky. Podle ministra školství Galina Tsokova nejde jen o nové vybavení, ale o změnu přístupu: učení prostřednictvím činnosti a propojování předmětů.
Projekt je financován z Plánu obnovy a odolnosti EU, celkově dosahuje investic téměř 270 milionů eur. Do konce roku 2025 projde rekonstrukcí přes


600 škol, další dočasně fungují z náhradních prostor. Každá instituce podle velikosti získává 25 až 300 tisíc eur.
Ambiciózní program však odhalil nedostatek učitelů přírodovědných oborů. Vláda proto spustila bezplatné studijní programy i rekvalifikace pro inženýry a do roku 2027 plánuje vyškolit 39 tisíc pedagogů v kompetenčně orientovaných modelech výuky.
Součástí změn je i reforma kurikula. Nové osnovy kladou důraz na digitální, sociálně-emoční i podnikatelské dovednosti, do závěrečných testů pro 7. a 10. ročníky přibydou integrované praktické úlohy. STEM výuka navíc stále častěji propojuje i umění a mezioborovou spolupráci učitelů.
Budoucnost na baterky? V Mnichově ukázali, že je elektrická a chytrá
Na veletrhu IAA Mobility 2025 v Mnichově se elektromobilita stala hlavní hvězdou.
Volkswagen představil dostupný model ID.2, Škoda zaujala konceptem Vision O a městským crossoverem Epiq. BMW ukázalo novou generaci iX3 s designem „Neue Klasse“, zatímco Audi a Cupra přinesly svěží koncepty budoucnosti, které kombinují sportovní charakter s udržitelností. Zásadní posun přinesla baterie Shenxing Pro
od CATL – dojezd až 758 km, nabití 478 km za pouhých 10 minut a životnost přes milion kilometrů. Funguje i v mrazu, zvládá nabíjení při –20 °C a slibuje revoluci v dostupnosti elektromobility pro širokou veřejnost.
Čínské značky jako AITO, XPeng, Leapmotor či AVATR ukázaly globální ambice – luxusní elektromobily, lokalizované kokpity, testy v extrémních podmínkách a důraz na design. AITO 9 míří na Blízký východ, XPeng láká evropské zákazníky atraktivní cenou i výbavou.V rámci
Open Space si návštěvníci vyzkoušeli e-kola, nákladní elektrokola i koloběžky přímo v ulicích Mnichova. IAA 2025 tak potvrdilo, že budoucnost
mobility je elektrická, propojená, chytrá a překvapivě blízko každodennímu životu. Konec LKR10. Drony dostávají nový prostor i pravidla
Od 1. září 2025 začínají v Česku platit nová pravidla pro provoz dronů v tzv. zeměpisných zónách. Dosavadní rámec LKR10 – UAS nahrazuje systém LKR310, který se dělí na konkrétní oblasti jako ochrana drah (LKR311), elektrická vedení (LKR312), letiště (LKR314, LKR315), hustě osídlené prostory (LKR316) či chráněná území (LKR318). Každá zóna má jasně definované podmínky, které mají zvýšit bezpečnost a přehlednost provozu.
Novinkou je možnost využít provozní scénáře místo individuálních povolení, což výrazně usnadní legální létání i v místech, která byla dosud přísně regulována. Největší změny se týkají oblastí kolem letišť, elektrických vedení a dalších prvků infrastruktury. Nový systém má za cíl zjednodušit administrativu a zároveň zpřístupnit létání širší veřejnosti.
Velkou pomocí bude digitální mapa dronových zón, dostupná od září na dronemap.gov.cz. Uživatelé si díky ní snadno ověří, kde mohou létat bez omezení, kde je nutné splnit podmínky, a kde je provoz zakázán. Mapa bude pravidelně aktualizována a dostupná i pro mobilní zařízení.
Nová pravidla se dotknou hobby pilotů i profesionálů. Přestože systém působí složitěji, jeho cílem je větší transparentnost, bezpečnost a dostupnost. Drony tak dostávají jasná pravidla a moderní nástroj pro orientaci v prostoru.



nových průmyslových zakázek v červenci 2025 meziročně vzrostla o 6,6 %.
Tahounem byla výroba motorových vozidel, kde se objem zakázek zvýšil o 15 %. Tuzemské zakázky posílily dokonce o 13 %, zatímco zahraniční poptávka vzrostla o 2,9 %.

Český průmysl zároveň zaznamenal v červenci meziroční růst produkce o 1,8 %, meziměsíčně pak o 0,8 %. Nejvíce k tomu přispěla výroba motorových vozidel a dále segment pryžových a plastových výrobků, zejména pneumatik. Růst vykázaly i podniky zaměřené na kovové konstrukce, kovodělné výrobky a elektrická zařízení. Pozitivně se promítla i nižší srovnávací základna v těžbě uhlí. Negativně se naopak projevila nižší výroba ostatních dopravních prostředků a zařízení, nápojů nebo textilií.
Vedle celkového růstu o 6,6 % je důležitým signálem i výrazný posun u tuzemských zakázek. Ty se meziročně zvýšily o 13 %, což potvrzuje, že český trh zůstává pro průmysl silným motorem. Zahraniční poptávka s růstem o 2,9 % sice zaostala, ale i tak potvrzuje stabilní zájem o českou produkci. „Růst nových zakázek v průmyslu nejvíce ovlivnila výroba motorových vozidel. Jejich hodnota se vlivem nízké srovnávací základny meziročně zvýšila o 15 %. Významné dlouhodobé zakázky uzavřely také podniky vyrábějící ostatní dopravní prostředky a zařízení,“ uvedla Veronika Doležalová, vedoucí oddělení statistiky průmyslu ČSÚ.

Navzdory pozitivnímu vývoji produkce i zakázek se průměrný evidenční počet zaměstnanců v průmyslu meziročně snížil o 1,9 %. Tento trend naznačuje, že podniky pokračují v hledání cest k vyšší efektivitě a částečně nahrazují pracovní sílu technologiemi a automatizací.
Podle Eurostatu se v červnu 2025 průmyslová produkce v EU27 meziročně zvýšila o 0,5 %. Český průmysl si polepšil jen o 0,2 %, což ukazuje na jeho stabilní, avšak spíše mírný růst v evropském měřítku. Tahounem byla výroba ve Švédsku, která meziročně vzrostla o 13,4 %, a v Irsku s růstem o 10,5 %. Naopak Německo, jako největší obchodní partner České republiky, zaznamenalo pokles o 3,8 %.


Zdroj: Český statistický úřad







Začínali jako COLSYS – AUTOMATIK, a.s., dnes působí pod názvem SYNERIQ, a.s. Od svého založení v roce 1998 se firma profiluje jako odborník na průmyslovou automatizaci, měření a regulaci a řízení technologických procesů. Postupně rozšířila svou specializaci také na návrh a realizaci průmyslových komunikačních sítí, oblast průmyslové komunikace a kybernetické bezpečnosti, a to zejména v oblastech energetiky, výroby a dopravní infrastruktury. Díky vlastnímu týmu vývojářů, projektantů a techniků poskytuje komplexní služby od návrhu přes realizaci až po následný servis.
Předseda představenstva Jiří Kasner, který je s firmou profesně spjat více než dvě dekády, v rozhovoru přibližuje, proč bezpečnost začíná už návrhem, jak probíhá modernizace živých systémů a proč se na výpadek musíte připravit dřív, než nastane.








Ve vaší práci je běžné budovat systémy, které musí fungovat nonstop a bez výpadků. Jak se dnes dá skloubit vysoká provozní spolehlivost s důsledným zabezpečením proti kybernetickým hrozbám?
Bez nadsázky se dá říct, že vše začíná u papíru a tužky. Jinými slovy, kvalitní návrh musí od počátku počítat s funkčností, bezpečností i obnovitelností. Návrh systému není jen o technických parametrech. Je to o důkladném pochopení toho, co provozovatel skutečně potřebuje. A pokud jde o systémy v kritické infrastruktuře, je takový přístup naprosto nezbytný.
Základními parametry musí být vysoká dostupnost, spolehlivost, integrita a důvěryhodnost. Jen samotná bezpečnost nestačí. Systém musí být navržen tak, aby bylo možné jej v rozumné době obnovit po výpadku nebo kybernetickém incidentu. A to není možné bez úzké spolupráce mezi dodavatelem a provozovatelem. Ideální je, když má zadavatel na své straně někoho, kdo systémům opravdu rozumí a dokáže se účastnit návrhu od začátku. Pokud ne, padá veškerá zodpovědnost na nás jako dodavatele. To ale nefunguje. Bezpečnost nelze koupit jako službu bez odpovědnosti na vlastní straně.
Návrh začíná dlouho před výběrem technologií. Nejdřív musíme vědět, co má systém umět, k čemu bude sloužit a v jakém prostředí bude fungovat. Až poté přichází výběr komponent, konfigurace, implementace a provoz. Když se tento sled naruší nebo přeskočí, může to vést
k zásadním problémům v ostrém provozu. Je to jako objednat si auto a dostat traktor. Možná do cíle dojedete, ale nebude to jízda, jakou jste si představovali.
Dnes často narážíme na nedostatek odborníků, kteří by rozuměli jak průmyslovým, tak bezpečnostním systémům. Mnoho rozhodnutí je činěno bez dostatečné znalosti předpisů a provozních zkušeností. A pokud v organizaci chybí někdo, kdo by sám dokázal určit bezpečnostní strategii, nemůže vzniknout smysluplné a odolné řešení. To všechno ukazuje, že kybernetická bezpečnost není jen doplňková technická vrstva navrch. Je to přístup, který musí být přítomný od samotného návrhu. A bez lidí, kteří systému rozumí, to nikdy nebude fungovat správně. Je to otázka odpovědnosti, vzdělávání, kultury i strategického plánování.
V prostředí, kde propojujete různé řídicí technologie s množstvím senzorů, měřičů a přenosových bodů, jak zajišťujete, aby data proudila spolehlivě a byla chráněna před zneužitím nebo ztrátou?
O bezpečnost se dále pak starají i koncová zařízení – servery, firewally a další prvky infrastruktury. Přenosová vrstva je tedy čistě transportní a zajišťuje stabilní doručení dat v čase a parametrech, jaké daný systém vyžaduje.
Při návrhu systému je proto důležité přesně vědět, co má být přeneseno, pro koho a v jakém rozsahu. Kombinace bezpečnosti, dostupnosti a výkonu musí být součástí designu hned od
začátku. Není totiž jedno, jestli navrhujeme řídicí systém pro energetiku nebo síť senzorů pro monitoring.
Například u ochran elektrických zařízení se pracuje s velmi rychlými ději. Tam si nemůžete dovolit zpoždění nebo výpadek. Jinak hrozí vážné technické problémy. Proto musí být komunikační infrastruktura navržena s předstihem tak, aby všechny možné poruchy zvládla včas detekovat a vyřešit. Pokud má například nějaký řídicí systém kontrolní cyklus okolo vteřiny, komunikační vrstva musí být schopna reagovat ještě rychleji.
U nových systémů, které stavíme takzvaně na zelené louce, je to jednodušší. Můžeme si dovolit vše promyslet od začátku. U rekonstrukcí je to mnohem složitější. Tam je často potřeba provést podrobnou analýzu, protože nové řešení musí zapadnout do stávající infrastruktury. A jakmile je komunikační vrstva poddimenzovaná nebo není správně navržena, naruší to funkčnost celého systému.
V průmyslových provozech často fungují starší řídicí systémy, které se nedají snadno aktualizovat. Jak se v těchto případech řeší zabezpečení, když nejde jednoduše „nainstalovat záplatu“?
Je pravda, že řada těchto systémů má extrémně dlouhý životní cyklus. V energetice nebo dopravní infrastruktuře není výjimkou, že systémy fungují deset nebo i dvacet let. Naopak bezpečnostní hrozby se vyvíjejí velmi
rychle a běžný způsob aktualizací, na který jsme zvyklí u telefonů nebo počítačů, zde zkrátka není možný.
V těchto případech se využívají takzvaná hranová řešení. Starý systém se neaktualizuje, ale obklopí se bezpečnostní obálkou, tedy kontrolovaným prostředím s přesně definovanými pravidly přístupu. Ideální je, pokud lze systém provozovat v ostrovním režimu, tedy úplně oddělený od zbytku světa. V takovém případě se minimalizují možnosti vnějšího zásahu a tím i riziko útoku.
O bezpečnost se pak stará moderní infrastruktura kolem. Starší zařízení obvykle nemají výkon ani kapacitu na to, aby zvládla šifrování nebo jiné bezpečnostní operace. Proto je důležité, aby ochrana probíhala na úrovni sítí, firewallů, přístupových politik nebo dedikovaných bezpečnostních prvků.
Zároveň je potřeba aktivně sledovat ohrožení. Každý provozovatel by měl znát známé hrozby, které se vztahují k jeho systému, a přizpůsobit tomu přijatá opatření. To zahrnuje nejen samotné záplaty, ale i rozhodnutí, zda je daná zranitelnost kritická nebo ne a jak přesně na ni reagovat v rámci dostupných možností.
Platí přitom jednoduchá úměra: čím je systém starší, tím větší bezpečnostní ohraničení kolem něj musí být. Některé vlastnosti se už nedají změnit, a proto je nutné vytvořit kolem nich co nejrobustnější bariéry.
Čím dál častěji se mluví o nutnosti rozdělit průmyslové sítě na menší bezpečnější celky. Jak se dá síť rozumně segmentovat, když máte ve výrobě směs historických zařízení, nových IoT prvků a různé komunikační protokoly?
Segmentace sítě je dnes jedním ze základních principů, jak ochránit zejména starší zařízení, která nelze zabezpečit jinak. Smyslem segmentace je nastavit systémy tak, aby mezi sebou komunikovaly jen tam, kde je to opravdu nutné a přesně definovaným způsobem. Každé rozhraní mezi dvěma systémy je potenciálním rizikem, a proto musí být dobře známé a řízené. Rozhraní může být pod kontrolou, omezené, nebo může kombinovat obě varianty podle konkrétní situace a požadavků provozu.V praxi se ale často stává,
že ani dodavatel přesně neví, jak jeho systém komunikuje. Zvlášť u moderních softwarových nástrojů, kde se propojení vytváří graficky bez hlubší znalosti samotné komunikace. Pro návrh bezpečného rozhraní je však nutné vědět, jak a proč data proudí, co je potřeba povolit a co naopak zablokovat.
Pro správný návrh je důležité pracovat s předpokladem, že každý jiný systém je z pohledu bezpečnosti nedůvěryhodný. Není to negativní přístup, ale forma preventivní ochrany. Výměna dat má probíhat pouze v nezbytném rozsahu a předem stanoveným způsobem.
běžné domácí zařízení může být při napojení na firemní infrastrukturu vážným bezpečnostním ohrožením.
To vše souvisí s obecnou potřebou mít nastavenou bezpečnostní strategii včetně segmentace, pravidel přístupu, pravidel komunikace a zejména jasné odpovědnosti. V novém zákoně o kybernetické bezpečnosti je tento přístup zohledněn. Posouvá se důraz od samotných zařízení ke službě, kterou firma poskytuje. S tím úzce souvisí i požadavek na spolehlivé dodavatele a schopnost systém obnovit. Setkali jsme se například s provozem, kde byl celý systém postaven na know-how člověka, který už několik let nežije. V případě poruchy tak firma neměla žádný způsob, jak systém obnovit, a to je riziko, které si dnes už nemůžeme dovolit přehlížet.
Řešení, která nabízíte, často propojují řízení, monitoring, přístupové systémy i kamerový dohled. Jak důležité je dnes mít všechna tato data propojená a schopná rychle reagovat na incident?
Systémy navržené pro maximální bezpečnost, dostupnost a bez výpadků.
Samostatnou kapitolou jsou vzdálené přístupy, které často představují slabé místo v celkové bezpečnostní architektuře. Problémem bývá připojení do výrobních systémů přes aplikace typu TeamViewer nebo jinou neřízenou virtuální privátní síť. Týká se to i cloudových služeb a VPN, kde mnohdy není správně nastavena ani identita uživatele, ani ochrana přenosu.
V takových případech nestačí spoléhat na přístupový certifikát nebo samotný nástroj. Musíte přesně vědět, kdo se k systému připojuje, proč a jaká má práva. V opačném případě si do sítě pouštíte rizika, která nemáte pod kontrolou. To platí dvojnásob v době, kdy se rozšířil model práce z domova. Ukázalo se, že oddělit pracovní a soukromé prostředí není snadné a že
Každé moderní řešení musí být od začátku navrženo tak, aby kromě technologií zahrnovalo i dohledové mechanismy a navazující procesy. Nejde jen o to odhalit chybu, ale dozvědět se o ní včas. Právě tato schopnost včasného zjištění je startovacím okamžikem pro udržení spolehlivosti nebo omezení rizika.
Pokud k incidentu skutečně dojde, je nezbytné mít připravený tzv. incident response plan. Ten musí zahrnovat nejen zodpovědné osoby a komunikační cesty, ale také technické prostředky, náhradní díly a jasně definovaný postup. Bez této předpřípravy riskujete zmatky, zdržení a ztrátu kontroly. Bohužel se stále stává, že firmy v krizové situaci netuší, kdo má daný systém na starost, kde je dokumentace nebo jak vůbec začít, a to je opravdu průšvih.
Důležitou součástí přípravy je také existence testovacího prostředí. Kritické systémy by měly mít možnost prověřit aktualizace nebo zásahy ještě před jejich nasazením do reálného provozu. Selhání této přípravy se ukázalo na známém případu, kdy aktualizace bezpečnostního softwaru způsobila celosvětový výpadek počítačů. Ukázalo se, že kritická infrastruktura byla napojena přímo na automatické aktualizace bez
předchozího ověření. V ideálním scénáři by se chyba projevila v laboratoři, nikoliv v ostrém provozu.
V průmyslovém prostředí je rozdíl mezi tím, když vypadne běžná kancelářská aplikace, a tím, když přestane fungovat systém řízení dopravy, distribuce nebo výroby. Na případu jednoho z evropských letišť bylo vidět, že zatímco místní infrastruktura byla v pořádku, výpadek na straně letecké společnosti způsobil naprostý kolaps nástupu cestujících a práci s odbavenými kufry. To ukazuje, jak důležité jsou funkční návaznosti a informovanost všech složek.
Právě tento typ uvažování reflektuje i nový zákon o kybernetické bezpečnosti. Posunul důraz od jednotlivých technických prostředků ke službě, kterou firma reálně poskytuje. Tím nejcennějším není konkrétní zařízení, ale schopnost poskytovat danou službu v požadované kvalitě a bezpečnosti. Technické prvky pak tvoří podpůrné prostředky, nikoliv cíl sám o sobě.
V řadě projektů přecházíte z historických řídicích systémů na moderní automatizační platformy. Co je při takové modernizaci nejtěžší?
A jak se dá zajistit, že upgrade nepřinese nové bezpečnostní mezery?
Modernizace bývá zpravidla migrační projekt, který se často odehrává za běhu, tedy za plného provozu. A to je přesně ta nejtěžší část. Návrh postupu musí být propracovaný do detailu, jasný přechodový plán a velmi přesné informace o tom, kdo, s kým, kdy a proč komunikuje. Nestačí jen technické výkresy. Hodně pomůže zkušenost „velínářů“. Ti totiž často vědí, jak se systém reálně chová i jak se nechová. Tyto znalosti jsou k nezaplacení.
Bezpečnostní mezery hrozí hlavně ve chvíli, kdy nové řešení nahrazuje staré bez dostatečné kontroly. Proto často po určitou dobu provozujeme starý i nový systém souběžně. Využíváme redundanci, a tam, kde to jde, se snažíme mít možnost vrátit se o krok nebo dva zpět. Samozřejmostí by měl být ověřovací plán každého kroku. V ideálním případě si vše nejprve vyzkoušíte nanečisto. Ne vždy to jde, ale pak musíte přesně vědět, jak systém správně zajistit. Například pokud zařízení nemá žádnou redundanci nebo v sobě nemá dostatečnou inteligenci, pak ho jednoduše musíte na chvíli odpojit, ale bezpečně a s rozmyslem.


Setkali jsme se i se systémy, které běžely přes pětadvacet let. To už je hodně stará technologie, ale i s takovým základem se dá pracovat. Každé prostředí má svá specifika, ale principy správné migrace a bezpečnosti zůstávají stejné: znalost, plán a odpovědnost.





















Evropa zpřísňuje pravidla pro digitální odolnost. A Česká republika není výjimkou. Od listopadu 2025 vstoupí v platnost nový zákon o kybernetické bezpečnosti, který zásadně promění dosavadní přístup k ochraně digitální infrastruktury. Na rozdíl od minulosti se již nebude týkat jen vybraných „kritických“ firem. Do povinného režimu spadnou tisíce organizací napříč průmyslem, veřejnou správou i službami.
„Listopad 2025 je blíž, než se zdá. Připravte svou organizaci včas a minimalizujte rizika.“
Zákon vzniká na základě evropské směrnice NIS2, jejímž cílem je zajistit, aby nejdůležitější systémy v Evropě byly chráněny proti kybernetickým hrozbám jednotně, systematicky a s jasnou odpovědností. Českým garantem je Národní úřad pro kybernetickou a informační bezpečnost (NÚKIB), který k zákonu připravil podrobný průvodce. Ten krok za krokem vysvětluje, co nová pravidla znamenají, koho se týkají a jak se na ně připravit.

Kdo se zákonem musí počítat Nová pravidla se týkají takzvaných poskytovatelů regulovaných služeb. Tedy firem a institucí, které spadají do jedné z určených kategorií podle velikosti, významu a charakteru služeb, které poskytují. Může jít o výrobní podniky, energetické společnosti, nemocnice, dopravní podniky, firmy z oblasti digitální infrastruktury, cloudové služby, banky i poskytovatele technické podpory.
Rozhodujícím faktorem pro zařazení je kombinace oboru a určité velikosti nebo dopadu služby. Subjekty, které spadají pod zákon, budou mít 60 dnů od účinnosti zákona, tedy od 1. listopadu 2025, na to, aby se zaregistrovaly a připravily na plnění povinností.
Na webu NÚKIB je k dispozici přehledný rozcestník, kde si může každá organizace ověřit, zda pod zákon spadá a jaká opatření se na ni vztahují. Právě včasné rozpoznání vlastní role je prvním a zásadním krokem, jak se vyhnout problémům.
Co se mění oproti současnému stavu Zatímco současná právní úprava platná od roku 2014 se týká jen úzkého okruhu „vybraných“ subjektů, nový zákon nastavuje mnohem širší rámec. Využívá princip kategorizace podle rizika a očekává, že firmy si nejen osvojí bezpečnostní opatření, ale také si je přizpůsobí vlastnímu provozu. Zákon klade důraz na tři hlavní oblasti:
» Technická opatření, jako je ochrana sítí, přístupových práv, zálohování a řízení zranitelností.
» Organizační opatření, tedy například školení zaměstnanců, odpovědnost managementu, plánování obnovy po útoku nebo jasně stanovené procesy pro hlášení incidentů.
» Spolupráce s NÚKIB, včetně ohlašovacích povinností, komunikace při incidentu a pravidelné aktualizace bezpečnostní dokumentace.

álnou proveditelnost. Firmy tak mají volnost v tom, jak konkrétní opatření zavedou, pokud tím naplní požadovaný výsledek, což je ochrana systémů a dat před narušením.
Proč to není jen další „povinnost z Bruselu“
Mnoho firem může vnímat nový zákon jako další administrativní břemeno. Ve skutečnosti jde ale o příležitost změnit přístup k bezpečnosti, která je dnes jedním z hlavních předpokladů stability každého podnikání.
Kybernetické útoky se netýkají jen bank nebo nemocnic. V posledních letech byly cílem vyděračských skupin i malé a střední firmy, logistické řetězce, dopravní společnosti nebo technologičtí dodavatelé. Výpadek systémů, únik dat nebo zablokovaná výroba se může během několika hodin proměnit v provozní i reputační krizi.
Zákon vytváří rámec, který má firmám pomoci se těmto scénářům vyhnout. Přináší jasné návody, metodiky, strukturu i podporu ze strany státu. A především zavádí principy, které dnes očekává i trh. Firemní partneři, odběratelé a investoři stále častěji zjišťují, jak jejich dodavatelé zacházejí s bezpečností. Nezabezpečený partner dnes může znamenat zranitelnost pro celý řetězec.
Praktický průvodce, který mluví srozumitelně
NÚKIB si je vědom, že nové povinnosti mohou působit složitě. Proto zveřejnil podrobný průvodce, který rozděluje proces do několika logických kroků. Organizace si tak mohou:
zákon.
2 Identifikovat své regulované služby.
3 Zvolit vhodný rámec bezpečnostních opatření.
4 Nastavit procesy a technická opatření.
5 Připravit dokumentaci a plán reakce na incident.
6 Zajistit komunikaci a reporting vůči státu.




Průvodce novým zákonem o kybernetické bezpečnosti
reálné zavedení bezpečnosti v praxi.
Čas běží. I když zákon vstoupí v účinnost až v listopadu 2025, příprava by měla začít co nejdříve. Firmy, které se chtějí vyhnout zmatkům, sankcím a bezpečnostním problémům, by si měly včas ujasnit svou roli, zapojit odpovědné lidi a sestavit plán zavádění.
Pro větší podniky to může znamenat nutnost reorganizace bezpečnostních týmů, přehodnocení smluv s dodavateli nebo investice do nástrojů pro správu identit a řízení přístupů. U menších firem může jít o outsourcing služeb, revizi školení nebo přípravu plánů obnovy. Důležité je, že nikdo nezůstává bez podpory. NÚKIB zveřejňuje metodiky, scénáře a připravuje informační kampaně, které mají pomoci všem typům organizací.
Nová pravidla nejsou hrozbou. Jsou signálem, že doba podceněné bezpečnosti skončila. Zákon o kybernetické bezpečnosti není o kontrole, ale o schopnosti chránit to nejcennější, a to provoz, data, důvěru. Přichází v době, kdy si Evropa i český průmysl uvědomují, že bez důvěryhodných systémů a lidí, kteří jim rozumějí, nebude možné dlouhodobě růst.
Firmy, které zvládnou přechod dobře, budou v očích svých partnerů i zákazníků silnější. A ty, které zareagují pozdě, budou možná jednou litovat, že ochrana dat a systémů nebyla součástí jejich firemní kultury dříve.
Digitalizace už dávno není jen o tom, že se přestanou tisknout papíry.
Dnes rozhoduje, jak firmy nastaví procesy, jak zacházejí s daty a jestli zvládnou reagovat na rychlost změn. Aleš Fukal, ředitel divize Digital Information Management ve společnosti Konica Minolta IT Solutions Czech, v rozhovoru vysvětluje, proč je bezpečnost stále podceňovaná, čím se liší prostředí v Česku a na Slovensku a proč se strategie musí přehodnocovat každých pár měsíců, nikoli jednou za pět let.












KDYŽ POROVNÁTE ČESKO A SLOVENSKO, LIŠÍ SE PODLE VÁS
JEJICH PŘÍSTUP K DIGITALIZACI?
Česko bylo vždy trochu napřed, hlavně v oblasti IT. Dnes už je západní Slovensko prakticky na stejné úrovni. Ale čím víc se posouváte na východ Slovenska, tím víc tam hrají roli osobní vazby, lokální firmy a soudržnost komunity. Digitalizace tam postupuje pomaleji. Je to dáno mentalitou, strukturou podniku a silnými osobními vazbami. Pamatuji si, když mi kolegyně z Rumunska řekla: „My vás vnímáme jako západ už od slovenských hranic.“ Překvapilo mě to, protože my sami se tak nevnímáme. Ale ukazuje to, že v Česku je prostředí a kupní síla o něco dál.


JAK SE V POSLEDNÍCH
LETECH MĚNÍ PŘÍSTUP
FIREM K DIGITALIZACI?
AI už není jen teoretická možnost. Dnes se bavíme o tzv. AI agentech, kteří dokážou vykonávat část práce samostatně, autonomně. Ale mají smysl jen tehdy, pokud mají kvalitní data. Pokud data nejsou správně připravená, žádná AI nepomůže.
Já sám jsem si vyzkoušel, že mi AI během chvíle vygenerovala kód, který fungoval téměř bezchybně a ušetřil mi tak hodiny práce. Přesto to nic nemění na tom, že lidská role je nezastupitelná. Kreativita, schopnost vyložit
výsledky a také je srozumitelně odprezentovat jsou dovednosti, které umělá inteligence převzít nedokáže.
ZMIŇOVAL JSTE BEZPEČNOST. JE TO PODLE VÁS NEJVĚTŠÍ PROBLÉM SOUČASNÉ DIGITALIZACE?
Ano. Bezpečnost je téma, které spousta firem odsouvá. Často slyšíte: „Mně se to nestane.“ A když se to stane, tak o tom zarytě mlčí. Přitom informace jsou to nejcennější, co firma má. V nich je mnohdy ukryté primární know-how společnosti.
Problém je i v tom, že firmy mají data rozházená na více místech, bez jasného systému a bez pořádného zabezpečení. A dokud se nic nestane, nikdo to neřeší. Jenže útoky si nevybírají. Útočníci vezmou to, co najdou. Viděl jsem příklad malé firmy, kterou dokázali během pár minut zablokovat jen proto, že majitel vyrazil na dovolenou, pustil si notebook na wifi síti hotelu, a neměl správně nastavené přístupy. A pak už bylo pozdě.
JE PODLE VÁS JEDNODUŠŠÍ
JEDNAT S VELKÝMI NEBO S MENŠÍMI FIRMAMI?
Každé má své. Velké firmy mají vlastní bezpečnostní týmy a složitou strukturu. Tam se dá spolehnout na profesionalitu, ale je to pomalejší. U menších firem je to často o majiteli nebo řediteli, který rozhoduje rychle. Právě u nich bývá ale největší problém s ochotou investovat. Bezpečnost berou jako něco, co „stojí peníze, ale nic nepřináší“. A to je chyba.
JAK DO TOHO VŠEHO ZAPADÁ VZDĚLÁVÁNÍ A MLADÁ GENERACE?
Mladí lidé mají technologie v krvi, umí s nimi pracovat a jsou rychlí. Často jim ale chybí trpělivost opravdu něco odpracovat. Všechno jim připadá jednoduché a chtějí
výsledky okamžitě. Realita je jiná. Kreativita, schopnost vysvětlit věci a srozumitelně je prezentovat, to jsou dovednosti, které se musí naučit.
Já se snažím, aby vzdělávání bylo přirozenou součástí práce. Strategie, kterou připravuji pro tým, se mění každého půl roku, někdy i kvartálně. To nás nutí neustále se učit nové věci. Důležité je, aby lidé vnímali vzdělávání jako něco naprosto samozřejmého.
JAK VYPADÁ VAŠE STRATEGIE, KDYŽ VÍTE, ŽE SE PODMÍNKY MĚNÍ PRAKTICKY KAŽDÉHO PŮL ROKU?
Strategii máme, ale je to živý dokument. Svět se mění tak rychle, že si nemůžeme dovolit ji držet pět let beze změny. Směr ale zůstává: být partnerem, který firmám ukazuje, kudy může vést jejich cesta, a být na té cestě s nimi. Konica Minolta má vizi do roku 2030 a já ji vnímám jako závazek. Nejde o to, jestli budeme mít přesně tyto produkty nebo jiné. Jde o to, že budeme stát vedle zákazníka jako důvěryhodný partner.
A KDYBYSTE MĚL NA ZÁVĚR
ZDŮRAZNIT TO NEJDŮLEŽITĚJŠÍ?
Bezpečnost, protože bez ní je všechno ostatní ohrožené. A adaptace, protože svět se mění rychle. Kdo se nepřizpůsobí, ten zůstane stát. A ještě bych dodal jednu věc: nebát se technologií. Nejsou tu proto, aby nás ohrožovaly. Jsou tu proto, aby nám byly nápomocny na naší pracovní i životní cestě. Naučíme-li se je využívat, posune nás to dál - všechny.










Frenštát pod Radhoštěm se stal na jeden den centrem debaty o budoucnosti českého průmyslu. Frenštátský Innomotics, výrobce nízkonapěťových elektromotorů, totiž uspořádal konferenci na téma „Stabilita v době nestability: jak zajistit udržitelnost českého průmyslu?“. Do výrobního závodu dorazily desítky odborníků z průmyslu, akademické sféry i byznysu.
Ekonomický pohled přinesl předseda Národní rozpočtové rady Mojmír Hampl: „Český průmysl dnes stojí před zásadní otázkou: jak obstát v době geopolitické a ekonomické nestability. Diskuze přímo ve výrobě jednoho z významných českých podniků je skvělým příkladem toho, jak hledat odpovědi tam, kde se průmysl reálně odehrává.“
Silný oborový rozměr pak zdůraznil prezident Elektrotechnické asociace Jiří Holoubek: „Elektrotechnický průmysl patří mezi páteřní odvětví české ekonomiky. Pokud má být udržitelný, musíme spojit digitalizaci, inovace a vzdělané lidi. Chuť i potenciál nechybí a pokud se skloubí s praxí podobně jako v Innomotics, máme vyhráno.“
Konference však nebyla jen o makrotrendech. Účastníci mohli přímo ve výrobě vidět, jak se inovace promítají do každodenní praxe. Innomotics představil například motory s permanentními magnety, které nabídnou až 2,5krát
vyšší výkon při menších rozměrech a až o 67 % nižší hmotnost. Díky moderní konstrukci dosahují účinnostní třídy IE5 a IE6 a při jejich výrobě se snižuje produkce CO2 až o 53 %.
Závod ale ukázal i nové přístupy k řízení výroby. Návštěvníci se seznámili s digitálním dvojčetem výrobního závodu, které umožňuje nejen sledovat provoz, ale také simulovat návrh pracovišť a celých technologických celků. Společnost prezentovala i využití datové analytiky a principů strojového učení k predikci zakázek, což je technologie, která může zásadně proměnit plánování a optimalizaci výroby.
„Konference ukázala, že nejde jen o zelené technologie. Jde především o to, jak se dokážeme přizpůsobit změnám a najít stabilitu v prostředí, které je stále méně předvídatelné. Právě propojení průmyslu, technologií a otevřené diskuze je cesta, jak posílit odolnost a konkurenceschopnost českého průmyslu,“ uzavřel Roman Valný
„Naším cílem bylo propojit teorii s praxí a ukázat, že stabilita průmyslu začíná právě zde – v inovaci a v lidech, kteří ji každý den tvoří,“ vysvětlil generální ředitel Innomotics ČR Roman Valný.

Mezinárodní strojírenský veletrh BRNO l 7.–10. 10. 2025 l MSV





Pokud bychom kybernetickou bezpečnost přirovnali k armádě, pak by Security Operations Center, zkráceně SOC, bylo jejím velícím štábem. Je to místo, kde se nepřetržitě sleduje, co se děje v digitálním prostoru firmy, a kde se rozhoduje o tom, jak reagovat na hrozby a útoky. Bez SOC by byla většina moderních podniků jako město bez policie a hasičů, otevřené nečekaným rizikům a neschopné rychle zasáhnout.

SOC je centrální centrum kybernetických operací. Najdete v něm týmy analytiků, inženýrů a manažerů, kteří mají jeden hlavní úkol: chránit digitální aktiva organizace. Do jejich péče spadá vše od serverů a firemních sítí až po cloudové prostředí, mobilní zařízení, aplikace a systémy, které dnes často využívají prvky umělé inteligence.
Práce SOC má několik zásadních částí. Monitorování IT infrastruktury probíhá nepřetržitě, dvacet čtyři hodin denně, sedm dní v týdnu. Představte si, že se účetní vaší firmy, která se vždy přihlašuje z Prahy, náhle ve tři hodiny ráno přihlásí do systému ze serveru v Asii. Nebo že systém, který běžně odesílá jen malé objemy dat, začne náhle stahovat gigabajty informací. To jsou přesně ty anomálie, které SOC okamžitě zachytí a prověří dřív, než mohou způsobit škodu. Pokud se hrozba potvrdí, nastupuje rychlá reakce na incident. Ta může znamenat









izolaci napadeného zařízení, blokaci přístupu z cizí adresy nebo dočasné vypnutí části systému, aby se zabránilo větším škodám.
SOC se ale nezabývá jen hašením požárů. Jeho úlohou je také dlouhodobě zlepšovat bezpečnostní úroveň firmy. To zahrnuje vyhodnocování slabin, doporučování aktualizací, správu přístupových práv a také školení zaměstnanců, kteří jsou stále častěji hlavním cílem útočníků. Kromě reakce na již probíhající incidenty se špičkové týmy SOC věnují i tzv. lovu hrozeb (Threat Hunting) Místo pasivního čekání na poplach aktivně pátrají v síti po stopách útočníků, kteří se mohli vyhnout automatizované detekci. Je to práce digitálních detektivů, kteří hledají sebemenší nesrovnalosti, jež by mohly značit skrytou hrozbu.
„Bez SOC by byla firma slepá a hluchá k digitálním hrozbám.“






MONITORING DE TEKCE REAKCE PREVENCE
Zatímco ještě před několika lety byla hlavní silou v SOC lidská odbornost, dnes stále více prostoru dostává umělá inteligence. Moderní systémy dokáží v reálném čase analyzovat obrovské množství dat, které by lidský analytik jednoduše nezvládl. Umělá inteligence se postupně učí, jak vypadá běžný provoz, a díky tomu rychle odhalí i nenápadné odchylky.
Velkým trendem jsou takzvaná agentní SOC, kde vedle lidí působí i autonomní agenti založení na umělé inteligenci. Ti se starají o rutinní úkoly, například třídění incidentů nebo vyhledávání souvislostí mezi jednotlivými událostmi. Díky tomu se zkracuje čas mezi detekcí a reakcí na incidenty z hodin na minuty a lidský tým se může soustředit na složitější analýzy a strategická rozhodnutí.
















„Čas mezi detekcí a reakcí se díky AI zkracuje z hodin na minuty.“

Kybernetické útoky se dnes netýkají pouze bank a technologických gigantů. Čím dál častěji míří na výrobní závody, energetické společnosti, dopravní podniky i logistické firmy. V automobilkách, ve strojírenství nebo v energetice hraje SOC zásadní roli, protože chrání nejen servery a počítače, ale i výrobní linky, roboty a celé systémy průmyslové automatizace.
V letectví se vedle vývoje nových technologií, například udržitelných paliv, řeší také digitální odolnost palubních systémů a infrastruktury řízení letového provozu. Zabezpečení těchto prvků není jen technickou záležitostí, ale otázkou bezpečnosti celé společnosti. Podobně robotika otevírá nové možnosti i rizika. Na Robotické olympiádě v Číně se sice soutěžilo o to, který robot je nejrychlejší nebo nejchytřejší, ale odborníci v zákulisí diskutovali i o tom, jak zajistit, aby tyto stroje nebyly zneužitelné k útokům.
Zvláštní pozornost si zaslouží i 3D tisk. Tento způsob výroby se stal pevnou součástí průmyslové praxe. Používá se k výrobě náhradních dílů, složitých součástek nebo prototypů, které by klasickými metodami vznikaly jen velmi obtížně. Data potřebná pro 3D tisk jsou však sama o sobě cenným knowhow. Únik těchto dat neznamená jen finanční ztrátu, ale může vést ke ztrátě konkurenční výhody, poškození reputace u zákazníků nebo v případě kritických dílů i k bezpečnostním rizikům. Dobře fungující SOC tak nechrání jen data, ale přímo klíčové know-how a stabilitu celého podniku.



Ne každá firma si může dovolit vlastní SOC. Vybudování nonstop centra se specialisty a odpovídajícím technologickým vybavením je nákladné. Proto je možné využít outsourcing. Poskytovatelé kybernetické bezpečnosti provozují vlastní centra SOC a dohled nabízejí formou služby. Firmy tak získávají profesionální ochranu bez nutnosti investovat do vlastního týmu a rozsáhlé infrastruktury.

Rozvoj digitalizace, průmyslu 4.0 a umělé inteligence posouvá hranice možností i hrozeb. Budoucnost SOC bude proto stát na kombinaci lidského úsudku a automatizace. Umělá inteligence umožní zrychlit reakce, prediktivní analýza nabídne možnost předvídat nové typy útoků a mezinárodní spolupráce usnadní sdílení informací o hrozbách napříč státy i obory.
Pro český průmysl to znamená jednoznačný závěr. Investice do SOC se stávají nezbytností. Příklady z energetiky, automobilového průmyslu i železnice ukazují, že bez centralizovaného řízení kybernetické bezpečnosti je provoz kritické infrastruktury stále zranitelnější. Společnost LokoTrain například spustila dvě moderní výcviková centra pro strojvedoucí, kde se vedle praktické přípravy diskutuje také o digitální bezpečnosti železniční infrastruktury.
SOC už není jen technologický pojem, ale základní předpoklad bezpečného fungování moderního podniku. Chrání data, zajišťuje stabilitu provozu a umožňuje firmám držet krok s rostoucími hrozbami digitálního světa. Ať už jde o továrnu, letiště nebo dopravní síť, investice do SOC už není volbou, ale strategickou nutností pro přežití v digitálním světě.







GREYCORTEX Mendel poskytuje detailní přehled nad komunikací a chováním aktiv ve výrobních a zpracovatelských firmách. Odhaluje kybernetické hrozby i provozní anomálie, pomáhá předcházet výpadkům a podporuje plnění kybernetického zákona.
Přehled napříč celou infrastrukturou. Jednotlivé týmy snadněji identifikují bezpečnostní rizika a udrží plynulý provoz.


Detekce známých i neznámých hrozeb v IT a OT prostředí snižuje riziko výpadků v řídicích systémech, ERP a dalších klíčových aplikacích.
Odhalování výpadků, zpomalení a anomálií v reálném čase i zpětně udržuje stabilitu výrobních procesů.

NOVÁ GENERACE VÝROBNÍCH LINEK A STROJŮ
PRO EFEKTIVNÍ A BEZOBSLUŽNÝ PROVOZ
Automatizace průmyslových procesů je jedním z klíčových trendů dnešní doby. Firmy hledají řešení, která jim umožní vyrábět rychleji, s vyšší přesností, menšími náklady a především bez závislosti na nepřetržité lidské obsluze. Společnost Bomar na tento vývoj reaguje a představuje novou generaci plně automatizovaných dělicích linek a výrobních strojů, které kombinují spolehlivost osvědčených technologií s moderními prvky automatizace a robotizace.
Naskenujte a podívejte se na automatickou dělicí linku v akci!













Naším cílem je nabídnout zákazníkům řešení, která umožní dlouhodobý bezobslužný provoz, vysokou produktivitu a maximální využití materiálu. Proto jsme v posledních letech zásadně inovovali jak jednotlivé pásové pily, tak kompletní dělicí linky.

NOVÁ AUTOMATICKÁ DĚLICÍ LINKA PRO VRSTVENÉ ŘEZÁNÍ
Jednou z významných novinek je plně automatická dělicí linka pro vrstvené řezání materiálů. Tento systém je koncipován jako ucelená jednotka od přípravy materiálu na vstupu až po jeho třídění po řezu.
Na vstupní straně se nachází plně zakrytovaný dopravníkový systém s vodicími lištami, z nichž jedna je nastavitelná pro přesné navádění materiálu. To zajišťuje bezpečný pohyb a stabilní uložení kusů do vrstvy.
Srdcem linky je automatická pásová pila Ergonomic 258 ANC, určená pro kolmé řezy. Díky automatickému podavači je pila schopna plně bezobslužného provozu.
● Osvědčená stabilita a vysoká produktivita
● Nově vybaveno kuličkovými šrouby a servopohony na všech osách


Přesnější a citlivější řízení řezu




Tímto způsobem lze vytvořit řešení na míru, které přesně odpovídá výrobnímu procesu zákazníka.
INTEGRACE S ERP SYSTÉMY A SOFTWARE SAWMANAGER


Automatizace není jen o strojích, ale i o chytrém propojení se softwarem. Moderní linky Bomar lze propojit se zákazníkovým ERP systémem, čímž je zajištěna nepřetržitá výměna dat.

Na výstupu je linka vybavena poháněným dopravníkem s integrovaným třídicím systémem. Materiál je po řezu automaticky směrován podle jeho délky:
● krátké kusy putují do sběrného boxu
● finální díly se oddělují pomocí hydraulické tlačné jednotky
● ostatní kusy pokračují dopravníkem až na konec trati, odkud je lze snadno odebrat
Vedle nových linek jsme inovovali i naši tradiční řadu Production, která patří mezi nejspolehlivější a nejvyužívanější stroje na světě. Díky své osvědčené stabilitě a produktivitě se tato řada stala ideálním základem pro další vývoj.
Nové stroje Production jsou nyní vybaveny kuličkovými šrouby a servopohony na všech osách, což umožňuje citlivější a přesnější řízení řezu. Do konstrukce jsme zapracovali zkušenosti z řad ProForce a ProCarbide, které se osvědčily i při práci s náročnými materiály, například titanem.



Naším cílem bylo připravit stroje nejen pro běžný automatický provoz, ale především pro budoucí integraci do plně automatizovaných řezacích center. Nová řada tak nabízí široké možnosti konfigurace
Tato řešení zajišťují, že i v plně automatickém režimu nedochází k prostojům ani ke snížení kvality výroby.
MODULÁRNÍ PŘÍSTUP A VARIABILITA ŘEŠENÍ
Každý zákazník má jiné požadavky, a proto Bomar staví na modulárním principu. Stroje lze vybavit řadou příslušenství a rozšíření:
● vstupní část může mít jednoduchý válečkový dopravník, kluzný dvojitý dopravník, řetězové příčné podavače či kapsový zakladač
● na výstupu lze použít jednoduché dopravníky, třídicí boxy, kartézské třídicí systémy nebo plně robotizované manipulátory
● k dispozici jsou i doplňková zařízení pro měření a kontrolu rozměrů nebo značicí jednotky






Náš software SawManager poskytuje okamžité výhody:
minimalizuje vznik zbytků

zkracuje přípravný čas


předává data přímo do řídicího systému stroje


vede „Naším cílem bylo připravit stroje nejen pro běžný provoz, ale pro integraci do plně automatizovaných center.“


jasně vede obsluhu při nakládání a manipulaci

Výsledkem je vyšší produktivita, nižší náklady a snadná kontrola výrobního procesu.
Automatizace je budoucnost a Bomar je připraven –ji svým zákazníkům nabídnout v té nejefektivnější podobě. Od menších dělicích linek přes modernizovanou řadu Production, až po sofistikovaná řešení s roboty a ERP integrací – vše je navrženo s důrazem na spolehlivost, produktivitu a flexibilitu.









„MANUTAN JE EXPERT NA VYBAVENÍ PRO PRŮMYSL, SKLADY, DÍLNY A KANCELÁŘE.“



















„Většinu výrobků privátní značky si necháváme vyrábět v Evropě co nejšetrnějšími postupy. Tím se zkracují přepravní trasy a podporují lokální výrobci, což snižuje uhlíkovou stopu. Zároveň Manutan rozšiřuje portfolio tzv. odpovědných produktů – zákazníci dnes pod jeho značkou najdou například kancelářské židle, šatní skříně, policové regály či dílenské stoly vyrobené z recyklovaných materiálů.“, uvádí Tomáš Martinek, Obchodní ředitel.



































V dnešním byznysovém prostředí hraje společenská odpovědnost firem (CSR) stále větší roli. Firmy všech oborů – včetně dodavatelů průmyslového vybavení – jsou pod rostoucím tlakem chovat se udržitelně a eticky. Zákazníci, obchodní partneři i veřejnost očekávají, že podniky budou minimalizovat negativní dopady na životní prostředí, podporovat své zaměstnance a komunity a jednat transparentně. Společnost Manutan, přední dodavatel vybavení pro firmy s více než padesátiletou tradicí, na tyto trendy reaguje a integruje CSR do všech aspektů svého podnikání. Staví na třech pilířích udržitelnosti – lepší planetě, lepší společnosti a lepším podnikání – které prostupují vším od výběru produktů a dodavatelů přes logistiku až po interní fungování firmy.

Po vzoru Evropské zelené dohody (Green Deal) se Manutan zavázal k opatřením snižujícím emise a šetřícím zdroje a svou nabídku neustále rozšiřuje o produkty z recyklovaných či recyklovatelných materiálů. Díky těmto krokům se CSR stává nedílnou součástí hodnoty, kterou Manutan svým zákazníkům přináší v oblasti vybavení průmyslových podniků i kanceláří.
Udržitelný sortiment a ekologická výroba
Jedním z nejviditelnějších projevů CSR v podání Manutanu je důraz na udržitelné produkty a šetrnou výrobu. Při zařazování produktů do nabídky – nejen pod privátní značkou Manutan EXPERT – firma klade mimořádný důraz na jejich ekologické aspekty a celkovou společenskou odpovědnost. Manutan, jako první evropský B2B distributor přijal přístup Product Environmental

Footprint (PEF) a z něj odvozené hodnocení
Product Environmental Impact Score (PEIS) pro své produkty. Do roku 2027 si klade za cíl touto metodikou ohodnotit 100 % položek svého sortimentu. Znamená to, že u vybraných produktů na e-shopu Manutanu dnes zákazník nalezne přehledné označení environmentální stopy na škále A–E, což výrazně usnadňuje výběr šetrnější varianty. Manutan tímto přístupem opět potvrzuje, že myslí na dalekou budoucnost.
Pro výběr produktů uplatňuje Manutan principy cirkulární ekonomiky. Udržitelnost podle firmy znamená využívat zdroje co nejefektivněji – prodlužovat životní cyklus výrobků a předcházet vzniku odpadu. Proto Manutan již řadu let provozuje Circular Hub a firemní outlet výprodejnu, kde nabízí vrácené či lehce poškozené zboží za zvýhodněné ceny místo toho, aby tyto produkty končily jako odpad. Zákazník tak získá kvalitní vybavení levněji a planeta je méně zatížena odpady. Navíc, mateřská společnost Manutan France, ve spolupráci s neziskovou organizací Ateliers Sans Frontières také sbírá, recykluje a daruje vysloužilé elektronické produkty – tím současně snižuje množství odpadu a pomáhá lidem v tíživé životní situaci najít uplatnění.
Udržitelnost v podání Manutanu zahrnuje i logistiku a dodavatelský řetězec. Společnost optimalizuje dopravu zboží tak, aby co nejméně zatěžovala ovzduší – konsoliduje objednávky, nasazuje úsporné technologie (např. robotické systémy AutoStore ve skladech) a pro mezinárodní přepravu využívá nízkoemisní přepravce. Díky programu FRET21 dokázalo například logistické centrum Manutanu snížit emise z dopravy o 7 % během tří let. A výběr dodavatelů? I ten podléhá odpovědným kritériím – Manutan má specializovaný nákupní tým, který zajišťuje, aby dodavatelé sdíleli vizi a závazky firmy. „CSR je přitom jedním z našich hlavních kritérií. Společnost tak pečuje o to, že odpovědný přístup je přítomen v celém hodnotovém řetězci od výroby až po doručení zákazníkovi.
Důraz na kvalitu a dlouhou životnost
S udržitelností úzce souvisí také kvalita produktů a jejich životnost. Investice do průmyslového vybavení totiž dává největší smysl, pokud výrobky dlouho a spolehlivě slouží – šetří to zdroje, náklady i čas. Manutan proto klade velký důraz na testování kvality a spolupracuje jen s prověřenými
výrobci. Kvalitu svých produktů testuje ve vlastní laboratoři, kde každý výrobek prochází dvojí kontrolou, aby spolehlivě obstál v každodenním provozu. Díky této interní kontrole kvality si může dovolit poskytovat na veškerý sortiment privátní značky prodlouženou záruku 10 let (a 3 roky na spotřební materiál) – což výrazně přesahuje běžný tržní standard.
Při výběru produktů do nabídky Manutan upřednostňuje výrobce s dlouholetými zkušenostmi a ověřenou kvalitou. Naše zkušenost potvrzuje, že sázka na kvalitu se vyplatí ekonomicky i environmentálně (méně odpadu a nižší frekvence obnovy vybavení). Manutan navíc pečlivě hlídá i dostupnost náhradních dílů a kontinuální nabídku oblíbených produktů, takže zákazník se může spolehnout, že konkrétní osvědčené zboží bude k dispozici i s odstupem času:
„I PO LETECH VIDÍME POPTÁVKY PO STEJNÉM NÁŘADÍ ČI TECHNICE. KDYŽ SI ZÁKAZNÍCI POŘIZUJÍ I PO MNOHA LETECH STEJNÝ PRODUKT, VÍME, ŽE JSOU SPOKOJENI A ŽE NAŠE NABÍDKA ODRÁŽÍ JEJICH POTŘEBY“ DOPLŇUJE TOMÁŠ MARTINEK.
Dlouhá životnost produktů tedy není jen technický parametr, ale i součást odpovědného přístupu –zákazník nemusí často nakupovat nové vybavení, šetří finance a zároveň snižuje svou ekologickou stopu. Kvalitní průmyslové vybavení Manutan tak představuje trvalou hodnotu, na kterou se firmy mohou spolehnout každý den.





PROČ JE CIRKULÁRNÍ EKONOMIKA ZÁSADNÍ PRO ČESKÝ PRŮMYSL?
Český průmysl stojí na prahu jedné z největších změn ve své moderní historii. Po desetiletí se spoléhal na lineární model výroby a spotřeby, který fungoval na jednoduchém principu: vytěžit, vyrobit, spotřebovat a vyhodit. Tento přístup se však ukazuje jako neudržitelný. Spotřeba primárních surovin roste, ceny energií a materiálů kolísají a tlak na dekarbonizaci se stává stále intenzivnějším. Firmy proto začínají hledat nové cesty, jak zefektivnit hospodaření se zdroji a současně obstát v rostoucí konkurenci.
Cirkulární ekonomika nabízí odpověď. Není to jen environmentální trend, ale komplexní strategie, která mění způsoby výroby, spotřeby a nakládání s odpady. Podle INSTITUTU CIRKULÁRNÍ EKONOMIKY (INCIEN) má právě Česká republika obrovský potenciál využít cirkulární principy k posílení vlastní ekonomiky, snížení závislosti na dovozu surovin a k vytvoření nových obchodních příležitostí.
OD LINEÁRNÍHO MODELU
K CIRKULÁRNÍMU – PROMĚNA
PARADIGMATU










Lineární hospodářství fungovalo v době, kdy byly zdroje levné a snadno dostupné. Dnes však čelíme realitě omezených zásob a stále přísnějších legislativních požadavků. Cirkulární ekonomika staví na opačném principu. Namísto krátkodobého využití materiálu hledá způsoby, jak jej udržet v oběhu co nejdéle. Odpady se přetvářejí v nové suroviny, produkty se navrhují s ohledem na snadnou recyklaci a firmy využívají technologie, které umožňují efektivní zpracování druhotných zdrojů.











Tento posun neznamená pouze změnu technologií, ale především změnu myšlení. Pokud lineární ekonomika vidí konec životního cyklu výrobku na skládce nebo ve spalovně, cirkulární ekonomika jej chápe jako začátek nové etapy. Tento přístup otevírá prostor pro inovace, nové obchodní modely a odolnější průmyslové strategie.

„I problematický odpad se může stát surovinou budoucnosti.“



TVRDÁ DATA A REALITA ČESKÉHO PRŮMYSLU
Podle údajů INCIEN vzniká v České republice ročně více než 30 milionů tun odpadů, přičemž více než polovina pochází z průmyslu, zejména ze stavebnictví, energetiky a zpracovatelského sektoru. Přesto je recyklováno pouze okolo 40 procent materiálů. Zbytek končí na skládkách či ve spalovnách, což znamená nejen environmentální zátěž, ale i ztrátu hodnotných zdrojů.
Odhady ukazují, že zavedení cirkulární ekonomiky by mohlo DO ROKU 2030 snížit spotřebu primárních surovin až o deset procent a přinést miliardové finanční úspory. Obzvlášť výrazný potenciál se ukazuje ve stavebnictví, kde lze recyklovat až devadesát procent některých druhů demoličních materiálů. Tyto údaje nejsou jen abstraktní vizí, ale konkrétním návodem, jak posílit hospodářství a snížit jeho zranitelnost vůči výkyvům světových trhů.
témy opakovaně použitelných kartonových obalů, které nacházejí uplatnění v logistice. Nafigate Corporation vyvinula biotechnologii Hydal, jež umožňuje výrobu biopolymerů z použitých fritovacích olejů. Tyto příklady dokazují, že odpad nemusí být břemenem, ale zdrojem pro tvorbu hodnotných produktů s novým životním cyklem.
V energetice se objevují projekty zaměřené na využití popílků, strusek a dalších vedlejších produktů spalovacích procesů. Namísto uložení na skládky mohou být využity jako suroviny pro stavební materiály nebo pro další průmyslové aplikace.
Bez technologií by cirkulární transformace nebyla možná. Digitalizace umožňuje detailní sledování toků materiálů a energií, optimalizaci výrobních procesů a snižování ztrát. Automatizace přináší efektivnější třídění odpadů a robotika umožňuje bezpečné a rychlé zpracování složitých materiálových směsí.
Velký význam má i vývoj nových materiálů. Společnost Silon Planá nad Lužnicí recykluje plasty a vyrábí z nich granuláty pro další průmyslové využití. GZ Media, největší výrobce vinylových desek na světě, testuje recyklaci polyvinylchloridu používaného při výrobě desek a hledá cesty, jak uzavřít vlastní materiálové cykly.
Cirkulární ekonomika se již v Česku prosazuje prostřednictvím pilotních projektů velkých firem i menších inovativních podniků. ŠKODA
AUTO pracuje na uzavírání materiálových cyklů ve výrobě a systematicky se věnuje recyklaci baterií z elektromobilů. Ikea Česká republika testuje nové formy opětovného využití nábytku, renovaci a systémy zpětného odběru. Ve stavebnictví se prosazuje projekt Skanska Rebetong, kde se beton vyrábí z recyklovaného stavebního odpadu.
Obalový průmysl přináší řadu inspirativních řešení. Společnost Model Obaly vyvíjí sys-
Digitalizace také otevírá cestu k novým obchodním modelům. Díky sledování životního cyklu výrobků lze zavádět modely pronájmu či zpětného odběru, které motivují výrobce k dlouhodobé udržitelnosti produktů.
SPOLUPRÁCE FIREM, AKADEMIE A STÁTU
Cirkulární ekonomika není jen technologickou otázkou, ale i otázkou spolupráce. Bez propojení průmyslu, akademických institucí a státní správy nelze dosáhnout plného potenciálu. INCIEN zdůrazňuje nutnost vzdělávání, sdílení knowhow a vytváření platforem, které spojují různé aktéry. Inspirativním příkladem je projekt Zálohujme.cz, který ukazuje, že systémové změny vyžadují širokou koordinaci a ochotu ke spolupráci napříč obory.



Cirkulární ekonomika nepřináší jen ekologické benefity, ale také konkrétní ekonomické výsledky. Firmy, které zavádějí cirkulární modely, často zaznamenávají úspory nákladů na suroviny a energie. Získávají lepší přístup k financím, protože investoři a banky stále více upřednostňují podniky, které mají udržitelnou strategii. Posilují svou reputaci u zákazníků, kteří vnímají ekologickou odpovědnost jako hodnotu.
Navíc se otevírají nové tržní příležitosti. Zpracování druhotných surovin, vývoj nových recyklovatelných materiálů či poskytování servisních a renovačních služeb představují rychle rostoucí segmenty trhu.
VÝZVY A PŘEKÁŽKY
Transformace však není bez obtíží. Patří mezi ně vysoké počáteční investice do nových technologií, složitá legislativa a často i nedostatek kvalifikovaných odborníků. Dalším problémem je zakořeněný lineární přístup v myšlení managementu a zákazníků. Přesto se ukazuje, že podniky, které dokážou tyto překážky překonat, získávají výraznou konkurenční výhodu.
MEZINÁRODNÍ INSPIRACE
ČESKÁ REPUBLIKA může čerpat inspiraci ze zemí, které jsou v zavádění cirkulární ekonomiky dále. NIZOZEMSKO patří mezi průkopníky, kteří si vytyčili jasný cíl stát se do roku 2050 plně cirkulární ekonomikou. Země rozvíjí rozsáhlé programy pro stavebnictví, kde více než 50 procent stavebních materiálů pochází z recyklátu, a systematicky zavádí požadavky na demontovatelnost budov. Nizozemský přístup ukazuje, že i složitý sektor, jakým je stavebnictví, může fungovat na bázi uzavřených cyklů. Významnou roli zde hraje i recyklace plastů, kde stát podporuje nejen technologické inovace, ale i vznik nových firemních ekosystémů zaměřených na zpracování a opětovné využití materiálů.
FINSKO sází na kombinaci přírodních zdrojů a technologických inovací. Díky silnému zázemí v oblasti výzkumu a vývoje se země stala lídrem v oblasti biotechnologií a bioekonomiky.
Projekty zaměřené na výrobu bioplastů ze dřeva, papíru nebo zemědělských zbytků ukazují, že suroviny lze nahrazovat materiály šetrnějšími k životnímu prostředí. Finská vláda také podporuje start-upy a univerzitní spin-offy, které se věnují vývoji nových recyklačních technologií, například pro textilní průmysl, jenž je globálně jedním z největších producentů odpadu.
DÁNSKO naopak spojuje cirkulární ekonomiku s rozvojem energetických komunit. Země je známá svými větrnými elektrárnami, ale méně se ví, že právě cirkulární principy stojí za tím, jak Dánsko nakládá s odpady a energetickými přebytky. Systémy dálkového vytápění jsou napojeny na využití průmyslového odpadu, tepla z výroby či z bioplynových stanic. Energetické komunity umožňují sdílení nejen elektřiny, ale i odpadu, který je zpracováván tak, aby sloužil jako zdroj pro nové výrobky nebo energie. Tento model přináší větší soběstačnost regionů a snižuje jejich zranitelnost vůči výkyvům globálních trhů.
Inspiraci lze hledat i v dalších evropských státech. RAKOUSKO patří mezi lídry v recyklaci komunálního odpadu a ukazuje, že kvalitní třídění a důsledná legislativa mohou přinést velmi vysokou míru materiálového využití. NĚMECKO se díky své tradici v oblasti průmyslu zaměřuje na rozvoj tzv. průmyslových symbióz, kdy vedlejší produkt jedné firmy slouží jako vstupní surovina pro jinou.
ŠVÉDSKO zase podporuje systém renovace výrobků a prodlužování jejich životního cyklu, a to i prostřednictvím daňových úlev na opravy.
Budoucnost cirkulární ekonomiky v Česku je úzce propojena s exportní politikou i energetickou soběstačností. Země, které dokážou zavést inovativní modely nakládání s druhotnými surovinami, získají výhodu na světových trzích. Český průmysl může díky tomu posílit svoji reputaci jako dodavatel udržitelných řešení a stát se partnerem, kterého preferují zahraniční investoři.
Recyklace a opětovné využívání materiálů zároveň posilují energetickou bezpečnost a snižují závislost na dovozu strategických surovin. Pokud se podaří zapojit více podniků do inovativních projektů a vytvořit prostředí, kde se cirkulární model stane standardem, může Česká republika výrazně posílit svou ekonomickou stabilitu a stát se inspirací pro další evropské země.

We live motion!

Lineární vedení a poLohovací systémy pro průmysLovou automatizaci a robotizaci






Beton je po vodě druhým nejpoužívanějším materiálem na světě. Stavebnictví se bez něj neobejde, ať už jde o výstavbu obytných domů, silnic, železnic nebo rozsáhlých infrastrukturních projektů. Jeho výroba je však spojena s vysokou spotřebou energie a zároveň se významně podílí na emisích oxidu uhličitého, protože cement, hlavní složka betonu, je odpovědný za 7 až 8 procent celosvětových emisí. V době, kdy Evropská unie i Česká republika směřují k udržitelnější ekonomice, je proto nezbytné hledat cesty, jak snížit ekologickou stopu stavebnictví. Jedním z nejperspektivnějších směrů je rebetoning – proces, který umožňuje znovu využít beton z demolic nebo rekonstrukcí a přeměnit jej na plnohodnotný stavební materiál.


JAK FUNGUJE REBETONING
Podstata rebetoningu spočívá v tom, že starý beton projde procesem demontáže, třídění a drcení. Vzniká tak recyklované kamenivo, které je následně využíváno pro výrobu nových betonových směsí. Pokročilé technologie navíc umožňují regenerovat i část cementové pasty, čímž se výsledný produkt přibližuje pevností a životností původnímu betonu. Tento proces znamená nejen úsporu přírodních zdrojů, ale i snížení emisí CO2, protože k výrobě nového cementu se spotřebuje méně energie.

Významnou výhodou rebetoningu je také to, že lze zpracovávat stavební suť přímo v regionech, kde vzniká. Tím se snižuje potřeba dovozu přírodního kameniva na dlouhé vzdálenosti a zároveň se omezují přepravní náklady. V praxi tak rebetoning propojuje ekologické přínosy s čistě ekonomickými výhodami.
PŘÍNOSY PRO PRŮMYSL I ŽIVOTNÍ PROSTŘEDÍ
Stavební a demoliční odpad tvoří více než třetinu celkového odpadu v Evropské unii. Pokud je tento materiál využíván jako surovina pro nové stavební projekty, dochází k výraznému omezení objemu odpadu ukládaného na skládky. Současně se šetří přírodní zdroje, protože těžba kameniva má často negativní dopady na krajinu a je v některých regionech omezena. Použitím recyklovaného kameniva lze podle odborných studií snížit uhlíkovou stopu betonu až o pětinu. Z ekonomického hlediska pak přináší výhodu především v oblastech, kde je těžba přírodního kameniva nákladná nebo kde jsou vysoké náklady na dopravu. Rebetoning tak dokáže propojit požadavky investora na hospodárnost s celospolečenským tlakem na snižování emisí a odpadů.




Recyklované kamenivo (RCA) vzniká drcením starého betonu. Díky tomu se snižuje množství odpadu ukládaného na skládky.“






Míra recyklace komunálního odpadu v EU (2022)
Recyklace komunálního odpadu v ČR (2021)
Recyklace obalového odpadu v ČR (2021)
Podíl stavebního a demoličního odpadu na celkové produkci v EU
Cíl pro recyklaci stavebního a demoličního odpadu v EU do roku 2025
Recovery rate (recyklace) C&D odpadu v EU (2010–2018)
Recyklace C&D odpadu v ČR (odhad 2006)
Produkce stavebního a demoličního odpadu v EU (2018) 44 %



Evropská agentura pro životní prostředí
EEA
EEA
Eurostat
Směrnice o odpadech (WFD)
Eurostat
DG Environment
Eurostat
Data ukazují, že ačkoliv je v Evropě recyklace stavebního odpadu poměrně vysoká, problémem zůstává jeho kvalitní využití ve stavebnictví. Česká republika má značný prostor pro zlepšení zejména v oblasti certifikovaných recyklátů, které mohou nahradit primární suroviny.





































































































OD SKANSKY
Česká republika má v oblasti rebetoningu své průkopníky. Jedním z nejvýznamnějších projektů posledních let je vývoj materiálu Rebetong, za nímž stojí společnosti Skanska, Skanska Transbeton a výzkumná firma ERC-TECH. Tento inovativní beton využívá stoprocentně recyklované kamenivo z betonu a cihel a je chráněn českým patentem. Podle testů dokáže snížit uhlíkovou stopu až o 10 % ve srovnání s běžným betonem.
První větší nasazení tohoto materiálu proběhlo na projektu Smíchov City v Praze, kde byl Rebetong použit při výstavbě nové městské čtvrti na místě bývalé továrny. Skanska zde ukázala, že recyklovaný beton není jen laboratorní zajímavostí, ale plnohodnotnou alternativou, kterou lze použít v rozsáhlých komerčních a rezidenčních stavbách.
INOVACE A EVROPSKÝ KONTEXT
Rebetoning není jen českou záležitostí. Evropská unie podporuje rozsáhlé výzkumné projekty, jako je například program ReCreate, který se zaměřuje na recyklaci prefabrikovaných betonových dílců. Pilotní projekty ukázaly, že tento postup může snížit spotřebu energie a emise až o 93 až 98 procent oproti výrobě nového materiálu. Cílem je ukázat, že i velké stavební celky lze konstruovat s využitím recyklovaných prvků, aniž by byla ohrožena jejich kvalita či bezpečnost.
Další směr představuje propojení rebetoningu s alternativními pojivy, jako jsou geopolymerní směsi, které samy o sobě produkují méně emisí než tradiční cement. Spolu s digitálním sledováním původu a složení stavebních materiálů tak vzniká komplexní nástroj pro zodpovědnější stavebnictví.




















Druhý nejpoužívanější materiál na světě po vodě.
PERSPEKTIVY PRO ČESKÉ STAVEBNICTVÍ
V českém prostředí zatím recyklovaný beton naráží na určitou nedůvěru investorů a projektantů, kteří dávají přednost tradičním materiálům. Zásadní je proto posílení certifikace, která dokáže prokázat kvalitu i bezpečnost recyklovaných směsí. Jakmile se podaří zvýšit důvěru trhu a podpořit využívání recyklátů například prostřednictvím veřejných zakázek, může se rebetoning stát standardní součástí stavební praxe.











Pro české stavebnictví jde o příležitost, jak spojit ekonomické a ekologické zájmy. Rebetoning může pomoci řešit nedostatek přírodního kameniva, snížit náklady na likvidaci odpadu a přispět k naplňování cílů cirkulární ekonomiky. Pokud se podaří posílit investice do technologií a rozšířit pozitivní příklady z praxe, může se Česká republika zařadit mezi evropské lídry v oblasti udržitelného stavebnictví.























Kvalitu, zkušenosti a flexibilitu
Veškeré služby pod jednou střechou – od konstrukce přes výlisek až po montáž
Certifikovaný systém řízení (ISO 9001, ISO 14001, IATF 16949, TISAX)
Technologie
○ tří a pětiosé obrábění, hloubení a řezání drátem
○ jedno a dvoukomponentní vstřikování (uzavírací síla 28 t – 500 t)
○ 3D měření (Zeiss, 3D skener Keyence)
○ 3D tisk (využití zejména na modely, přípravky, držáky atd.)
Odpovědný přístup k životnímu prostředí
LETOS JSME
S VÁMI OSLAVILI


Nářaďovny jsou v automobilovém a strojírenském průmyslu nepostradatelným článkem. Vznikají v nich lisovací formy, přípravky a měřicí zařízení, bez nichž by se sériová výroba nemohla rozběhnout. Každý díl karoserie, od dveří přes kapoty až po nosné části, prochází rukama nástrojařů. Jejich práce je zásadní také při modernizaci modelů, kdy je nutné připravit nové formy pro inovované díly.
V českém průmyslu mají nářaďovny dlouhou tradici. Už v první polovině 20. století byly součástí velkých strojírenských podniků a podílely se na výrobě automobilů, kolejových vozidel i letadel. Byla to právě tato specializovaná pracoviště, která umožňovala zavádění nových výrobků do sériové produkce. Dodnes platí, že bez nářaďoven by žádná automobilka nemohla fungovat.
KOPŘIVNICKÁ TRADICE
V MODERNÍM KABÁTĚ
Na tuto tradici navazuje TAWESCO v Kopřivnici. Do své nářaďovny investuje systematicky od roku 2011, celkem více než 730 milionů korun. Velký posun nastal po vstupu společnosti do skupiny Promet Group, kdy proběhla rozsáhlá modernizace. Zateplené haly, nové střechy a moderní vytápění snížily energetickou náročnost o tři čtvrtiny. Dalších více než 230 milionů korun směřovalo do technologií a vybavení. Dnes zde pracují stroje od evropských výrobců, jako jsou TRIMILL, Schuler Group nebo Diffenbacher.
Nářaďovna má dnes rozlohu přes 7 600 metrů čtverečních a zaměstnává 180 odborníků. Ti vyrábějí lisovací formy o hmotnosti až 40 tun
a rozměrech v řádu několika metrů, svařovací nářadí, kontrolní a měřicí přípravky či celé prototypové výrobky. Rozsah výroby umožňuje realizovat i projekty, na které by si mnoho firem netrouflo.
NEJVĚTŠÍ
Velký důraz se v posledních letech klade na digitalizaci. Moderní nářaďovny fungují s využitím CAD/CAM systémů, které umožňují připravit a optimalizovat výrobu forem už ve virtuálním prostředí. Díky simulacím lze předem odhalit možné problémy a ušetřit čas i materiál. Nedílnou součástí je také 3D měření a kontrola přesnosti, která zaručuje, že forma bude odpovídat požadavkům zákazníků. TAWESCO tyto trendy využívá a kombinuje je s dlouholetými zkušenostmi svého týmu.
Výrobky z Kopřivnice se uplatňují u významných zákazníků. Formy z TAWESCA se používají při výrobě dílů pro značky Škoda Auto, Volkswagen, Mercedes nebo John Deere. To dokládá, že české strojírenství si udržuje konkurenceschopnost i v mezinárodním prostředí, kde se klade důraz na přesnost, spolehlivost a rychlost dodávek.


Kopřivnice je průmyslové město s bohatou historií a automobilová výroba k ní neodmyslitelně patří. Nářaďovna tuto tradici rozvíjí a současně přetváří do podoby odpovídající potřebám 21. století. Propojuje moderní technologie, energeticky úsporný provoz a know-how lidí, kteří dokážou skloubit konstrukční práci s precizní výrobou.
Nářaďovny i v éře digitalizace a automatizace zůstávají nenahraditelnou součástí průmyslového ekosystému. Virtuální modely a simulace dokážou výrobu urychlit, ale fyzické formy jsou stále nutné pro každý nový model automobilu nebo stroje. TAWESCO je příkladem, jak se tento tradiční obor proměňuje, aniž by ztratil svůj význam. Jeho nářaďovna je největší ve střední Evropě a patří mezi pracoviště, kde se formuje budoucnost evropského automobilového průmyslu.
Inzerce






















Podniková energetika se nachází v období, které lze bez nadsázky označit za přelomové. Evropské i české fi rmy se musejí vyrovnávat s cenovými výkyvy, s novými regulačními požadavky a zároveň s tlakem na snižování emisí. To vše proměňuje způsob, jakým podniky přistupují k nákupu energií. Není to už jen administrativní úkol, ale strategické rozhodování s přímým dopadem na konkurenceschopnost.

Ještě před několika lety byl běžnou praxí model, kdy si podnik zafixoval cenu elektřiny nebo plynu na celé období smlouvy. To přinášelo stabilitu a jednoduché plánování nákladů. Dnešní trh se však vyvíjí mnohem rychleji. Ceny energií reagují na geopolitické události, počasí i dostupnost obnovitelných zdrojů. Fixace na dlouhé období proto může být nevýhodná.
Stále častěji se proto využívají flexibilní modely nákupu. Patří mezi ně postupné nákupy po menších částech nebo navázání spotřeby na aktuální
tržní ceny. Takový přístup umožňuje rozložit riziko a využít příznivých podmínek, když ceny klesají. Firmy si tak mohou nastavit mix jistoty a flexibility podle své spotřeby a finanční strategie.
Digitalizace jako základ řízení spotřeby
Dalším zásadním trendem je digitalizace. Moderní energetika už není jen o fyzické dodávce komodity, ale o práci s daty. Firmy dnes mají k dispozici zákaznické portály a analytické nástroje, které zobrazují spotřebu v reál-
ném čase, porovnávají ji s historickými daty a nabízejí predikce vývoje. Díky těmto technologiím je možné plánovat odběry tak, aby se minimalizovaly špičky, které jsou pro podniky finančně náročné. Digitalizace také usnadňuje reporting směrem k vedení firmy nebo k investorům a stává se podmínkou pro efektivní energetický management.
Udržitelnost a role obnovitelných zdrojů
Energetická rozhodnutí podniků dnes ovlivňuje i rostoucí důraz na udržitelnost. Evropská
legislativa i tlak zákazníků vedou firmy k tomu, aby stále častěji využívaly elektřinu z obnovitelných zdrojů. Praktickým řešením jsou například záruky původu nebo přímé smlouvy o nákupu energie z konkrétního obnovitelného zdroje (tzv. Power Purchase Agreements – PPA).
Výhodou je nejen nižší uhlíková stopa, ale často i stabilnější cena v dlouhodobém horizontu. Podniky, které takové smlouvy uzavírají, si navíc budují pověst odpovědných partnerů a posilují svoji pozici vůči zákazníkům i dodavatelům.
Energetika jako součást firemní strategie
Dříve bylo řízení nákupu energií úkolem oddělení nákupu. Dnes se tato agenda dostává na úroveň strategického řízení. Spotřeba energie ovlivňuje finanční výsledky, environmentální profil i schopnost firmy reagovat na nové požadavky trhu.
Proto se stále více rozvíjí poradenství a dlouhodobá spolupráce s dodavateli, kteří firmám pomáhají nejen s dodávkou samotné komodity, ale i s optimalizací spotřeby, analýzou rizik nebo zaváděním technologií pro úspory. Energetika se tak stává oblastí, která zasahuje do výroby, financí i komunikace s veřejností.

Směřování podnikové energetiky
Budoucnost firemní energetiky bude podle odborníků stát na třech pilířích:
► Flexibilní nákupní strategie, které kombinují fixaci s využíváním spotového trhu.
► Digitální řízení spotřeby, jež poskytuje podrobné údaje o odběrech a umožňuje jejich optimalizaci.
► Udržitelný přístup, který zahrnuje využívání obnovitelných zdrojů a snižování uhlíkové stopy.
Podniky, které tyto přístupy dokážou propojit, získají stabilnější náklady, vyšší důvěru obchodních partnerů a připravenost na budoucí regulace.










Mnoho majitelů a ředitelů B2B výrobních firem věří, že své zákazníky dobře znají. Obchodníci s nimi přece komunikují denně a spolupráce často trvá roky. Praxe ale ukazuje něco jiného. Podle studie Bain & Company si 80 % firem myslí, že zákazníkům poskytuje výjimečný zážitek. Ve skutečnosti to potvrdilo jen 8 % zákazníků. To ukazuje na obrovskou propast mezi tím, co si firmy myslí, a tím, co zákazníci skutečně vnímají.







Daniel Musil Co-owner & RevOps Evangelist
Stačí
mluvit s deseti zákazníky a získáte 80 %
klíčových poznatků, které vám otevřou oči.“

V průmyslu je tato mezera ještě výraznější. Zákazníci totiž nekupují jen „stroj“ nebo „komponenty“. Hledají jistotu, že technologie zvýší efektivitu, sníží prostoje a udrží kvalitu. Pokud komunikace stojí pouze na technických parametrech a ceně, míjí často to, co je pro zákazníky nejdůležitější.
Proč firmy zákazníky „neslyší“?
Důvodů je hned několik. B2B společnosti se příliš spoléhají na obchodníky, kteří sice mají přímý kontakt, ale informace často filtrují podle toho, co pomůže uzavřít obchod. Další častou chybou je zaměňování interních hypotéz za fakta – vedení se domnívá, že ví, co zákazník potřebuje, protože to fungovalo dříve, nebo protože to vidí u konkurence. A v neposlední řadě chybí systematický sběr a vyhodnocení zpětné vazby. Informace zůstávají roztříštěné mezi jednotlivými obchodníky a nikdy se nespojí do jednoho celku.


Jak hloubkové rozhovory odhalí skutečné potřeby
Jedním z nástrojů, jak tuto mezeru překlenout, jsou hloubkové rozhovory se zákazníky. Nejde o klasický dotazník ani obchodní call, ale o strukturovaný rozhovor, který pomáhá odhalit skutečné motivace nákupu, problémy a rizika, s nimiž se zákazník potýká, celý rozhodovací proces včetně faktorů, které do něj vstupují. A také očekávání, nejen technická, ale i servisní, logistická či vztahová.
Výrobce průmyslových kompresorů se domníval, že zákazníci oceňují hlavně výkon, spotřebu a cenu. Rozhovory ale ukázaly, že rozhodující je dostupnost servisu a rychlá oprava, protože denní výpadek znamená milionové ztráty. Velkou roli hrála i nízká hlučnost, kterou firma sama nepovažovala za konkurenční výhodu a nikde ji nekomunikovala. Po změně strategie, kdy důraz kladla právě na servis a hlučnost, vzrostla poptávka o 25 % během jediného roku. Nezávislý pohled funguje
Zákazníci se často více otevřou třetí straně než svému dodavateli. Obávají se, že jejich kritická zpětná vazba bude brána osobně nebo že skončí „v šuplíku“. Externí facilitátor dokáže rozhovory vést neutrálně a výsledky převést do konkrétních doporučení pro marketing, obchod i inovace.
Hloubkové rozhovory dnes využívají i české průmyslové firmy. Pomáhají jim postavit strategii na faktech, ne na domněnkách, a tím se odlišit v prostředí, kde technické parametry a ceny už často nestačí.









BORSODCHEM MCHZ ZA PLNÉHO PROVOZU



Rozvodná síť společnosti BorsodChem MCHZ potřebovala nutně zrekonstruovat. Přestávala být spolehlivá a nesplňovala aktuální bezpečnostní normy.
Rekonstrukce energetické infrastruktury probíhá ve spolupráci se společností ABB, a to bez přerušení výroby. Nově budovaný systém je digitálně řízený, s vysokou úrovní automatizace a je připravený na budoucí rozvoj.

BorsodChem MCHZ je významným výrobcem chemických produktů pro průmysl, farmacii i zemědělství. Jeho ostravský závod s téměř 400 zaměstnanci dodává produkty do celého světa a patří k největším technologickým provozům v regionu. Spolehlivá energetická síť je zásadní pro plynulý a bezpečný chod výroby.
Rozvodná síť v BorsodChem MCHZ byla postavená z velké části v 60. a 70. letech a její spolehlivost začala postupně klesat. Náhradní díly přestaly být dostupné a některé prvky nesplňovaly současné bezpečnostní normy.
Proto se v BorsodChemu rozhodli pro postupnou obnovu rozvoden vysokého a nízkého napětí. Zásadní podmínkou přitom bylo zvládnout celou rekonstrukci za chodu, aby výroba mohla běžet dál bez omezení. Ještě před samotnou rekonstrukcí zpracovali v BorsodChem interní studii, v rámci které se rozhodli pro robustní a uživatelsky přívětivé řešení od ABB.
Výsledek shrnuje Ing. David Kupec, vedoucí energetiky v BorsodChem
MCHZ: „Nahrazovali jsme zařízení, které už bylo na hranici své životnosti, a dobře jsme si uvědomovali, jak klíčové je spolehlivé napájení pro celý areál. Při výběru nového řešení jsme kladli důraz hlavně na kvalitu, spolehlivost a bezpečnost obsluhy – a to všechno rozváděče a spínací prvky od ABB splňují. Dodávky probíhaly přesně podle plánu a víme, že i do budoucna máme zajištěný servis. Z našeho pohledu jsme zvolili správně.“
Vyšší bezpečnost a snadnější obsluha s novými rozváděči UniGear ZS1
Modernizace distribuční sítě zahrnuje kompletní výměnu rozvodných zařízení včetně kabeláže a nových kabelových tras. Veškerá technologie
přitom musí být perfektně propojena s velínem rozvodu proudu, aby bylo možné centrálně řídit a monitorovat celý energetický systém.
Rozváděče v této infrastruktuře fungují jako pomyslné srdce sítě. Proto v ABB navrhli rozváděče pro BorsodChem na míru, včetně inženýringu a projektového řešení.



V BorsodChem potřebovali opravdu spolehlivý a bezpečný rozvodný systém – takový, který obstojí i v extrémně náročných provozech, jako jsou například jaderné elektrárny, vrtné plošiny nebo zaoceánské lodě. A právě proto jsou základem celého systému rozváděče UniGear ZS1. V ostravské chemičce bylo nainstalováno celkem 123 polí tohoto vzduchem izolovaného rozváděče.
Pro snadné řízení napájení a přehled v reálném čase o chování sítě s možností detekovat případné odchylky, jsou rozváděče vybavené ochranami řady Relion a elektronickými senzory pro přesné měření proudu a napětí. Ovládání zařízení je intuitivní a umožňuje pokročilý monitoring a vzdálenou obsluhu.
Pro každý provoz je klíčová bezpečnost personálu a omezení škod při poruchách. Díky systému zábleskové ochrany REA a ultrarychlému uzemnění UFES reagují rozváděče extrémně rychle – elektrický oblouk zanikne za méně než 4 ms.
Přehled o síti na dálku, komunikace v protokolu IEC 61850
V rámci další části projektu dodalo ABB 45 klasických rozváděčových kobek, vakuové vypínače VD4, kombinované senzory proudu a napětí KEVCD a opět ochrany řady Relion. V provozu chemického závodu takové veli-
kosti je nezbytné mít okamžitý přehled o stavu sítě i o hodnotách elektrických veličin – ideálně i na dálku. Proto je součástí instalace implementace výkonových jističů řady Emax2 a Tmax XT s pokročilými ochrannými spouštěmi Ekip Touch Measuring. Díky nim lze potřebné informace sledovat lokálně na přístrojích, ale i z velína prostřednictvím komunikačních protokolů.
Celé řešení využívá standardizovanou komunikaci na bázi protokolu IEC 61850 pro výměnu dat mezi zařízeními v reálném čase. Protokol podporuje GOOSE zprávy (Generic Object Oriented Substation Event) pro velmi rychlé přenosy událostí (např. ochranné signály), funguje na běžných síťových technologiích (TCP/ IP, MMS) a dokáže spolupracovat mezi zařízeními od různých výrobců.
Rozvodná síť je připravená na Průmysl 4.0 a další rozvoj
Modernizace energetické infrastruktury v BorsodChem MCHZ přináší náhradu zastaralé technologie a zásadně zvyšuje úroveň bezpečnosti provozu i jeho digitalizaci. Klíčovou roli hrají moderní senzory a digitální ochranné prvky, které umožňují přesné měření a rychlou reakci na změny zatížení bez nutnosti zásahů do samotné infrastruktury.
Součástí řešení je také komplexní garanční i pogaranční servisní podpora, která zajišťuje bezproblémový a kontinuální provoz celého systému. Celý projekt stojí na úzké spolupráci odborných týmů ABB a využívá zázemí výrobního závodu v Brně.














Ještě před deseti lety dominovala karosářským konstrukcím konvenční ocel. Dnes se ale situace rychle mění. Automobilky masově nasazují vysocepevnostní oceli (AHSS), hliník, kompozity a v prémiovém segmentu i uhlíková vlákna. Cílem je jediné – snížit hmotnost a zároveň zachovat nebo zlepšit bezpečnost a tuhost.
Lehčí karoserie znamená delší dojezd pro elektromobily a nižší spotřebu pro vozy se spalovacím motorem. Z hlediska emisí a efektivity výroby jde o zásadní parametr, který rozhoduje o konkurenceschopnosti značky.
Elektromobilita
Elektromobily přinesly do BiW úplně nové požadavky. Karoserie musí být nejen lehká, ale také extrémně tuhá, protože nese těžký bateriový modul. To urychluje vývoj multimateriálových řešení, kde se kombinuje ocel, hliník a kompozity podle konkrétních vlastností a požadovaných parametrů.
Body-in-White (BiW) označuje fázi výroby automobilu, kdy je karoserie kompletně sestavena z plechových dílů, svařena, slepena nebo snýtována, ale ještě není nalakována ani osazena dalšími komponenty. Tato část výroby se na první pohled může zdát rutinní, ve skutečnosti však představuje jednu z nejdynamičtěji se vyvíjejících oblastí automobilového průmyslu. Důvody jsou jasné: tlak na snižování hmotnosti, přechod k elektromobilitě a zavádění nových technologií.
Pro automobilky to znamená investice do nových výrobních technologií a úzkou spolupráci s dodavateli. BiW se tak stává oblastí, kde se nejvíce propojuje konstrukční inženýrství, materiálová věda a průmyslová robotika.
a digitální výroba
BiW dílny patří mezi nejvíce automatizované části automobilky. Robotické svařování, lepení a laserové řezání jsou už standardem. Nově se prosazuje využívání digitálních dvojčat, která umožňují simulovat výrobní procesy ještě před spuštěním linky.

Do popředí se dostává i 3D tisk, zejména u prototypových a malosériových dílů, kde výrazně urychluje vývoj a snižuje náklady. Zrychlení, přesnost a flexibilita jsou dnes základními atributy BiW výroby.
Evropa udává směr především díky přísným emisním normám a legislativě zaměřené na udržitelnost. Automobilky zde masivně investují do lehkých materiálů a ekologičtější výroby. Asie, zejména Čína, dominuje v objemu produkce a díky státní podpoře elektromobility rychle posiluje i technologicky.
Podle aktuálních studií dosahuje globální trh
s BiW v roce 2025 hodnoty přes 100 miliard dolarů a v příštích letech má dále růst. Rozhodující roli přitom budou hrát právě nové materiály a schopnost dodavatelů přizpůsobit se požadavkům výrobců.
Velký prostor dostávají kompozitní materiály. Uhlíková vlákna a vysokopevnostní polymery nabízejí ideální kombinaci nízké hmotnosti, pevnosti a designové flexibility. Zatím se používají hlavně u sportovních a prémiových vozů, postupně se ale prosazují i do širšího segmentu. Některé automobilky už vyvíjejí speciální typy kompozitů s nižší hustotou než titan, ale s vyšší pevností.
BiW přes 100 miliard dolarů v roce 2025










Co to znamená pro český průmysl?
České firmy, které se podílejí na výrobě komponent a nástrojů pro BiW, stojí před obrovskou příležitostí. Rostoucí poptávka po lehkých konstrukcích a multimateriálových řešeních znamená šanci zapojit se do globálních dodavatelských řetězců s vysokou přidanou hodnotou.

Úspěch ale nebude záviset jen na ceně, ale i na schopnosti inovovat a investovat do moderních technologií. Pro český průmysl je proto oblast BiW nejen výzvou, ale také příležitostí stát se součástí nové éry automobilové výroby.





NOVINKA PRO ROK 2025:
TEPELNÝ BOX HB


2 velikosti - až pro 2 IBC nebo 8 sudů efektivní ohřev až do 120 °C optimální izolace a energetická účinnost standardizované řešení za příznivou cenu

NAVŠTIVTE NÁS NA MSV: stánek č. 36, pavilon A2


































































Pokročilé asistenční systémy řidiče patří k nejdynamičtěji se rozvíjejícím oblastem automobilového průmyslu. Jejich cílem je zvýšit bezpečnost, zpříjemnit jízdu a připravovat cestu k autonomní mobilitě. Funkce, které byly ještě před deseti lety výsadou luxusních modelů, se dnes stávají standardem dostupným i v masově vyráběných automobilech.
Historie těchto technologií sahá do devadesátých let, kdy se na trhu objevily první protiblokovací systémy ABS a stabilizační programy ESP. Následovaly asistenty pro udržování jízdního pruhu, adaptivní tempomaty nebo systémy pro nouzové brzdění. Zpočátku šlo o relativně jednoduché algoritmy reagující na konkrétní vstupy ze senzorů. Postupem času se však množství dat zvýšilo natolik, že vznikla potřeba komplexnější interpretace.
● CO VLASTNĚ ZNAMENÁ
ZKRATKA ADAS?
Zkratka ADAS pochází z anglického Advanced Driver Assistance Systems, tedy pokročilé asistenční systémy řidiče. Pod tento pojem spadá široká skupina technologií, jejichž úkolem je podporovat řidiče při řízení, snižovat riziko nehod a zároveň zvyšovat komfort cestování.
Mezi funkce, které se dnes objevují i ve střední třídě vozidel, patří například adaptivní tempomat udržující bezpečnou vzdálenost od vozidla vpředu, asistent pro udržování v jízdním






pruhu, systémy nouzového brzdění nebo rozpoznávání dopravních značek. V městském provozu se čím dál častěji využívají parkovací asistenty, které zvládnou i plně automatické zaparkování bez zásahu řidiče.


Pokročilejší systémy, zatím dostupné hlavně u prémiových značek, zahrnují asistenci při jízdě v kolonách, poloautomatické předjíždění nebo propojení vozidla s infrastrukturou. ADAS systémy se také dělí podle úrovní automatizace od podpůrných funkcí (úroveň 1 a 2) až po částečně autonomní řízení (úroveň 3 a vyšší). Většina sériově vyráběných aut je dnes na úrovni 2, kdy má řidič nad vozidlem plnou kontrolu, ale část úkonů mu usnadňuje technologie.
Podle studií Evropské komise může zavedení moderních asistenčních systémů snížit počet dopravních nehod až o čtvrtinu. Technologie reagují rychleji než člověk a eliminují chyby způsobené únavou nebo nepozorností. Stejně významný je i komfort: dlouhé cesty jsou méně stresující a městský provoz zvládnutelnější. ADAS tak představuje krok směrem k plně autonomním vozům.
technologie.



radary a často i lidary. Úkolem není jen sběr




Současná vozidla jsou vybavena kamerami, radary a často i lidary. Úkolem není jen sběr dat, ale i jejich interpretace. Bosch proto vyvinul modulární architekturu, která kombinuje různé vstupy a vytváří ucelený obraz situace. Tento systém reaguje podobně jako zkušený řidič a dokáže rychle přizpůsobit chování vozidla aktuálním podmínkám. tém reaguje podobně jako vání vozidla aktuál-








Další vrstvu přidává generativní AI. Vision language action modely propojují počítačové vidění, zpracování jazyka a plánování akcí. Dokážou odhadnout širší souvislosti a vyhodnotit možné následky. Pokud se na vozovku skutálí míč, systém rozpozná, že může následovat dítě, a upraví reakci vozu.
● KONTEXT MÍSTO ČAR A OBDÉLNÍKŮ
Dříve byly asistenční systémy omezené a redukovaly prostředí na jednoduché čáry a tvary. Moderní foundation modely dnes umožňují mnohem citlivější vnímání a lepší zvládání i neobvyklých situací. Bosch navíc vyvinul metody, jak rozsáhlé modely zjednodušit, aby mohly běžet přímo v automobilech v reálném čase. Díky tomu nejsou závislé na cloudu a fungují i na cenově dostupných čipech, což je zásadní pro jejich masové rozšíření.
Vývoj AI v automobilovém průmyslu probíhá po celém světě. V USA se testují plně autonomní vozy, v Asii se klade důraz na rychlou integraci do městské dopravy a Evropa volí postupný vývoj s důrazem na bezpečnost a standardizaci. Bosch se profiluje jako lídr díky spojení výzkumu a sériového nasazení. Do vývoje investují také Mobileye, Nvidia nebo Continental. Společným cílem je přiblížit se lidskému způsobu řízení a snížit riziko chyb. Český kontext
Česká republika má v tomto vývoji aktivní roli. Bosch zde provozuje vývojová centra v Českých Budějovicích a Jihlavě. Zdejší týmy se podílejí na vývoji softwaru, testování i implementaci do konkrétních projektů. Zapojení domácího výzkumu ukazuje, že Česko není jen výrobní základnou, ale i místem, kde vznikají technologie s globálním dopadem.


TECHNOLOGIE
UMĚLÉ
INTELIGENCE
V SYSTÉMECH



ADAS (POKROČILÉ ASISTENČNÍ SYSTÉMY ŘIDIČE).


Nová generace ručního svařování MIG/MAG
Stejně flexibilní jako vaše každodenní práce
Řada přístrojů Fortis nabízí až 240 optimalizovaných charakteristik, které byly speciálně vyvinuty pro požadavky výroby ocelových konstrukcí, a spolehlivý svařovací výkon.
Více informací naleznete: www.fronius.cz/fortis
Kromě oceli zvládá svařovací přístroj MIG/MAG snadno i materiály, jako je hliník a nerezová ocel, zejména v kombinaci s pulzním obloukem.
● DOPADY NA SPOLEČNOST
Rozvoj ADAS a AI má širší společenské dopady. Otevírá otázky týkající se pojištění, odpovědnosti při nehodách nebo pravidel provozu. Přináší také tlak na infrastrukturu, která musí být připravena na komunikaci s vozidly prostřednictvím technologií V2X.
Pro uživatele je ale nejdůležitější, že technologie zvyšují bezpečnost a komfort. Postupem času se budou systémy stále více přibližovat lidskému uvažování a přinesou nové standardy mobility.

● BUDOUCNOST ASISTOVANÉHO ŘÍZENÍ
Podle odborníků je umělá inteligence základem pro to, aby asistované a automatizované řízení bylo bezpečnější a přirozenější. Modulární architektura umožní nasazení v různých třídách vozidel a připraví cestu pro masové rozšíření. Vývoj směřuje k tomu, že asistenti budoucnosti nebudou jen reagovat na podněty, ale budou chápat kontext a dokážou předvídat. To přiblíží automobilový průmysl k plně autonomní mobilitě, která může zásadně proměnit dopravu v evropských městech i na celém světě.


































Když potřebujete spolehlivost v každém pohybu.
Ať už zapojujete stolní lampu, nebo instalujete elektroinstalaci v kuchyni, potřebujete kabel, který se přizpůsobí – prostoru, pohybu i vašim nárokům. Flexibilní kabely NKT jsou navrženy tak, aby vám usnadnily práci a vydržely každodenní zátěž. Vyrobené v EU, testované na spolehlivost, připravené na každou výzvu.
Představte si to: jste v úzké kuchyňské skříňce, snažíte se protáhnout kabel za spotřebič. Každý centimetr se počítá. Právě tady oceníte flexibilitu, kterou kabely NKT nabízí.

Lehce se ohýbají, drží tvar a přitom neztrácí nic ze své odolnosti.





Vyrobeno v EU – garance kvality, bezpečnosti a souladu s normami
Flexibilita, která zjednodušuje práci –ideální pro místa s častým pohybem nebo omezeným prostorem. U našich kabelů jde snadno oddělit plášť od izolace, což ocení každý elektrikář.
Dlouhá životnost a spolehlivost – kabely testované pro každodenní nasazení
Zázemí silné značky s tradicí – partner, na kterého se můžete spolehnout

KABELY H03VV-F A H03VVH2-F


Ideální pro lampy, rádia nebo kancelářské vybavení. Flexibilní, nenápadné, ale spolehlivé. Přesně to, co potřebujete pro pohodlný domov i efektivní kancelář.



KABELY H05VV-F A H05VVH2-F






Zvládnou víc než jen běžný provoz. Jsou připravené na vysavače, pračky i lednice – a to i v náročnějším prostředí. Když potřebujete výkon a bezpečí v jednom.












KABEL H07V-K



Spolehlivý vodič pro pevné a bezpečné zapojení. Ideální pro pevné instalace, světla, ovládací panely. Když jde o bezpečnost, není prostor pro kompromisy.

ERP systémy (Enterprise Resource Planning) patří k základním technologiím, na kterých dnes stojí řízení podniku. Z nástroje určeného primárně k administrativě a evidenci se v posledních letech stal komplexní zdroj dat a podklad pro strategická rozhodnutí. Firmy, které dokážou využít pokročilou analytiku a reporting v ERP naplno, získávají nejen rychlejší přehled o svém fungování, ale i schopnost předvídat budoucí vývoj a přizpůsobit se měnícím podmínkám trhu.
Tradiční ERP systémy sloužily hlavně k tomu, aby se v nich zaznamenávaly účetní operace, skladové pohyby nebo objednávky. Hodnota spočívala v tom, že data byla centralizovaná a všichni zaměstnanci pracovali s jedním zdrojem pravdy.
Současný trend ale posouvá ERP mnohem dál. Firmy už nechtějí mít data jen uložená, ale potřebují z nich získávat odpovědi. Analytické moduly dnes dokážou data nejen shromažďovat, ale také interpretovat. Automaticky vytvářejí přehledy o tom, jak se vyvíjí výroba, jaká je ziskovost zakázek nebo jaké jsou největší položky ve struktuře nákladů.
Reporting jako každodenní nástroj rozhodování
Zásadní roli hraje reporting. Manažeři potřebují mít informace dostupné v okamžiku, kdy o nich rozhodují, a v podobě, která je srozumitelná. Moderní ERP proto nabízí interaktivní dashboardy s možností filtrovat a proklikávat se až na úroveň jednotlivé zakázky nebo výrobní operace.
Díky tomu se rozhodování stává podstatně rychlejší. Například finanční ředitel vidí v reálném čase stav cash-flow a může okamžitě reagovat na případné odchylky. Výrobní manažer sleduje vytížení linek a plánuje
směny tak, aby nedocházelo k prostojům. Reporting se tak stal nedílnou součástí každodenní práce managementu.
Prediktivní a doporučovací funkce
Další úroveň přináší prediktivní analytika. Moderní ERP systémy umí na základě historických dat a trendů předpovídat budoucí vývoj. To je užitečné například při plánování zásob, kdy dokáže systém upozornit na možné nedostatky dříve, než nastanou.
Některé systémy jdou ještě dál a nabízejí doporučovací funkce. Pokud například prodej klesá

v určitém regionu, ERP navrhne manažerovi, aby se zaměřil na konkrétní produkty nebo posílil marketing v daném segmentu. Umělá inteligence a strojové učení umožňují zpracovávat obrovské objemy dat a hledat vzorce, které by člověk jen těžko odhalil.
Propojení s moderními technologiemi


ERP se dnes neomezuje jen na interní data. Díky integraci s dalšími systémy lze propojovat například údaje z e-shopů, CRM nebo výrobních linek v rámci konceptu Průmysl 4.0.
Velký posun přináší cloud a mobilní technologie. Manažeři mají přístup k analytice odkudkoliv, mohou reagovat i na cestách a nemusí čekat na report připravený analytikem. Rozhodování se tak zkracuje z dnů na hodiny, někdy dokonce na minuty.
Přínosy pro podniky
Přesnější rozhodování: díky datům v reálném čase je možné rychle reagovat na změny v ekonomice, výrobě i na trhu.
Efektivnější plánování výroby a zásob: predikce pomáhají předcházet nedostatkům i nadbytečným zásobám.

Výhody pokročilé analytiky a reportingu v ERP se projevují v několika rovinách:

Vyšší transparentnost: vedení má jasný přehled o tom, jak firma funguje, a může lépe komunikovat s investory či bankami.
Úspory a optimalizace: detailní přehled nákladů ukazuje, kde lze hledat úspory, a pomáhá odhalit neefektivní procesy.
Podpora udržitelnosti: firmy mohou sledovat spotřebu energií, materiálů nebo emise a využívat data pro environmentální reporting.
Budoucnost ERP analytiky
formám. To umožní kombinovat interní údaje s externími zdroji, například s daty o trhu, počasí nebo dodavatelských řetězcích. Výsledkem bude ještě přesnější pohled na podnikání a možnost reagovat dříve, než se objeví problém.
Roste i význam vizualizace a uživatelské přívětivosti. Manažeři nechtějí zdlouhavě studovat tabulky, ale potřebují okamžitý vizuální přehled. Proto se očekává, že se do ERP bude stále více integrovat umělá inteligence, která dokáže shrnout data do jednoduchých doporučení.

Podle odborných studií se ERP systémy budou vyvíjet směrem k otevřeným datovým plat-
PROČ SE VYPLATÍ INVESTOVAT
Firmy, které investují do pokročilé analytiky v ERP, získávají konkurenční výhodu. Nejde jen o zlepšení vnitřních procesů, ale i o schopnost rychle reagovat na požadavky zákazníků, investorů nebo regulačních orgánů.









Lakovací linky často zahrnují procesy vyžadující ohřev, chod výkonných čerpadel, vzduchotechnické jednotky a další technologické operace, které spotřebovávají značné množství elektrické i tepelné energie. Součástí těchto linek bývají také chemické procesy a oplachy, což vede k vysoké spotřebě vody a vzniku odpadních látek.
Ve společnosti AABO-IDEAL navrhujeme a vyrábíme veškeré instalace a komponenty s důrazem na energetickou úspornost a šetrnost k životnímu prostředí. Náš vývojový tým se zaměřuje na optimalizaci spotřeby energie a snižování emisí CO2. V tomto směru pokračujeme i nadále, a právě proto jsme vytvořili program GO GREENER.
TEPELNÁ ČERPADLA GO GREENER PŘINÁŠEJÍ VÝHODY JAK ŽIVOTNÍMU PROSTŘEDÍ, TAK I DLOUHODOBÝM FINANČNÍM VÝSLEDKŮM.

Silný důraz na zelenou transformaci v posledních letech přinesl velkou poptávku po iniciativách, které zajišťují větší udržitelnost, lepší využití energie a nižší emise CO2. To je obzvlášť patrné po roce 2019, kdy EU spustila Green Deal s řadou konkrétních cílů.
GO GREENER je název volitelného balíčku vybavení pro lakovací linky, který podporuje vědomé nakládání s energií. Zaměřujeme se na vývoj efektivních a úsporných řešení a tam, kde je to technicky i ekonomicky možné, implementujeme systémy pro rekuperaci energie. Sledujeme vývoj ekologických technologií a trendy na trhu, abychom mohli našim zákazníkům nabídnout řešení, která odpovídají současným požadavkům na udržitelnost.
Společnost AABO-IDEAL vyvíjí již několik let ekologická řešení a systémy s co nejnižší spotřebou energie v oblasti povrchových úprav. S programem GO GREENER nyní
přinášíme další možnost, jak přizpůsobit povrchové úpravy náročnějším environmentálním požadavkům. Řešení nabízíme ve třech základních balíčcích:
BASIC: koncept vyvážení vzduchu, který zajišťuje rovnováhu mezi přívodem a odvodem vzduchu z procesů a budov
BASIC PLUS: koncept vyvážení vzduchu doplněný o systém rekuperace tepla
EXTENDED: systém rekuperace tepla vybavený inteligentními tepelnými čerpadly, který vrací ztrátové teplo zpět do procesu Balíčky se vyznačují vysokou účinností, chytrým řízením energetických toků v celém systému a nízkou uhlíkovou stopou. Jsou koncipovány jednoduše – ve třech standardních variantách – a zaručují bezpečnost díky jednotnému řídicímu systému a jediné certifikaci CE.
V lakovacím průmyslu jsou emise CO2 často vysoké, zejména při polymerizaci nebo přípravě povrchů. Naším cílem je pomoci zákazníkům tyto dopady snižovat, aniž by museli
slevovat z kvality nebo výkonu svých zařízení. Optimalizace spotřeby energie přináší nejen lepší ekonomické výsledky, ale i pozitivní dopad na životní prostředí. Věříme, že čím dříve začneme snižovat emise CO2, tím lépe.
V posledních letech jsme vyvinuli nástroje pro přesné poradenství při výběru zařízení optimalizujících spotřebu energie. Zákazníci si mohou zvolit rozsah řešení od základních kroků až po komplexní balíčky pro dosažení zeleného profilu výroby. Naše řešení se liší velikostí i složitostí, ale ve většině případů umožňují výrazné snížení emisí CO2
Pomocí výpočtových nástrojů založených na reálných datech z provozu našich lakovacích linek dokážeme odhadnout úspory energie i dopad na hospodářský výsledek firmy. U standardních systémů lze při využití balíčku GO GREENER dosáhnout snížení emisí CO2 až o 20 %. Na základě konkrétních parametrů instalace jsme schopni vypočítat roční úspory energie, snížení emisí i ekonomický přínos.







BRNO ZÍSKÁ NOVÉ CENTRUM PRO VÝVOJ A VÝROBU
V Brně vzniká nové vývojové a výrobní centrum společnosti Thermo Fisher
Scientific, které po dokončení v roce 2026 nabídne přibližně 60 tisíc metrů čtverečních moderních prostor, včetně až 11 tisíc metrů čtverečních čistých místností pro precizní výrobu elektronových mikroskopů.
Projekt má přinést až dva tisíce kvalifikovaných pracovních míst, prohloubit spolupráci s VUT Brno a posílit postavení České republiky v oblasti laboratorní techniky, elektronové optiky a exportu high-tech produktů.
Thermo Fisher Scientific patří k předním světovým producentům laboratorní a analytické instrumentace, biofarmaceutických služeb a řešení pro průmyslový výzkum. Působí ve více než 60 zemích, zaměstnává přes 100 tisíc odborníků a dosahuje ročního obratu přes 40 miliard dolarů. Brněnská pobočka má dlouhodobě silnou pozici v rámci skupiny a patří mezi významné české exportéry high-tech zařízení.
Nové brněnské centrum
Výstavba v areálu Královopolská začala na jaře 2025 a dokončení se očekává v průběhu roku 2026. Z plánovaných 60 tisíc metrů čtverečních bude část vyhrazena pro čisté prostory nezbytné pro výrobu vysoce přesných elektronových mikroskopů. Budova je navržena s důrazem na stabilitu
prostředí, energetickou účinnost a šetrnost k životnímu prostředí. Kromě výrobních hal nabídne coworkingové zóny, moderní laboratoře a prostory pro vzdělávání i odpočinek zaměstnanců.
Centrum má ambici stát se nejen výrobní základnou, ale i místem pro špičkový výzkum a vývoj. Strategickým partnerem je Vysoké učení technické v Brně, které zajišťuje vědeckovýzkumnou spolupráci, přístup k talentovaným studentům a společné vzdělávací programy.
Tahoun exportu a průmyslových inovací Brněnská pobočka Thermo Fisher Scientific dodává mikroskopy a spektrometry do desítek zemí světa. Přístroje nacházejí uplatnění ve vědeckých laboratořích, zdravotnictví, materi-
álovém výzkumu, automobilovém a leteckém průmyslu. Firma dlouhodobě podporuje vzdělávání — přibližně 70 % stážistů po ukončení praxe nastupuje na trvalý pracovní poměr. V roce 2025 společnost investovala více než 600 tisíc korun do nové laboratoře pro školení a vývoj.
Projekty a technologický rozvoj
V současnosti Thermo Fisher v Česku realizuje projekt „Thermo Fisher Scientific Brno, Weisz“ (HS6322430), zaměřený na rozvoj technologických řešení v letech 2024–2025. Portfolio firmy zahrnuje laboratorní produkty, biofarmaceutické služby a vývoj analytických nástrojů. V této oblasti brněnské centrum dlouhodobě dosahuje nadprůměrných výsledků jak z hlediska tržeb, tak technologických inovací.

60 000 m² nových prostor
Více než 100 000 zaměstnanců po celém světě
Více než 60 zemí 70 % absolventů



Poslání a společenský přínos
Propojení s českými dodavateli
Rozvoj Thermo Fisher v Brně je úzce propojen s českými dodavateli. Příkladem je spolupráce s firmou P&V ELEKTRONIC spol. s r.o., která dodává elektromagnetické vinuté díly a komponenty pro elektronovou optiku a měřicí techniku. Tyto komponenty jsou nezbytné pro spolehlivý chod špičkových přístrojů a představují důležitý článek výrobního řetězce. Spolupráce s lokálními firmami posiluje celé průmyslové prostředí v České republice.
Mise Thermo Fisher zní: „Umožnit zákazníkům učinit svět zdravějším, čistším a bezpečnějším.“ Tento závazek se promítá do trvalých investic do výzkumu, vývoje a vzdělávání, stejně jako do řešení pro zdravotnictví, vědu a průmyslovou bezpečnost. Společnost úzce spolupracuje s univerzitami, výzkumnými institucemi i průmyslovými partnery ve střední Evropě.
Společným úsilím jednotlivců, firem a státu můžeme vytvořit bezpečnější online prostředí pro všechny.



KDYŽ SVĚTLO ŠETŘÍ MILIONY
Moderní průmyslová výroba stojí na efektivitě. Každá investice, která snižuje náklady a zároveň zlepšuje podmínky pro zaměstnance, je dnes vítaným krokem vpřed. Jedním z nejrychleji návratných opatření je modernizace osvětlení. Přechod na LED technologie a chytré řízení přináší nejen úsporu energie, ale i větší komfort a bezpečnost práce.
Společnost E.ON Energy Solutions v posledních letech realizovala řadu projektů v českém průmyslu. Tři z nich – ve firmách REDA, Baker Hughes BRUSH Power Generation a GUMOTEX – dobře ukazují, jak rozdílné podmínky mohou vést k různým řešením, ale vždy ke stejnému výsledku: k výrazným úsporám a spolehlivějšímu provozu.
BAKER HUGHES BRUSH POWER GENERATION: MONTÁŽ, KDE MUSELI NASTOUPIT HOROLEZCI
Obrovská hala, která kdysi sloužila pro výrobu generátorů do jaderných elektráren, procházela rozsáhlou rekonstrukcí. Jedním z kroků byla i výměna zastaralých výbojek za moderní LED osvětlení.
Původní reflektory s příkonem přes 2 kW byly nahrazeny třiceti LED svítidly s výkonem necelých 600 W. Nový systém dokáže automaticky stmívat podle intenzity denního světla i podle provozních potřeb. Podle výpočtů to přinese úsporu až 71 % a návratnost investice do 2,5 roku.
Instalace však nebyla jednoduchá. Probíhala ve výšce kolem třiceti metrů nad otevřeným prostorem. Technici využívali mostový jeřáb a na některé práce museli nastoupit i horolezci. Celá montáž se navíc musela sladit s výměnou topného systému, aby se předešlo stínění či přehřívání.

Po dokončení je v hale stabilní intenzita světla minimálně 500 luxů, což ocení každý, kdo se věnuje přesné technické práci.

CO PŘINESLA MODERNIZACE
V BRUSH
● třicet nových LED svítidel s regulací
● až 71% úspora energie (dle kalkulací)
● návratnost 2,5 roku

● instalace ve výšce 30 m za pomoci horolezců
● stabilní osvětlení min. 500 luxů


Výrobce reklamních produktů REDA potřeboval snížit spotřebu energie a zároveň zlepšit pracovní prostředí. Firma zvolila cestu, která byla rychlá, bezpečná a nevyžadovala žádné zásahy do stávající infrastruktury.
Nová LED svítidla vybavená pohybovými a přítomnostními čidly se zapínají jen tehdy, když je to skutečně potřeba. Díky tomu není nikde zbytečně rozsvíceno a spotřeba elektřiny klesla na minimum.
Instalace probíhala i ve výškách kolem 16 metrů, ale bez přerušení výroby. Zaměstnanci tak pracovali v běžném režimu, zatímco technici postupně měnili stará světla za nová.
Dalším přínosem je možnost nastavit intenzitu i teplotu světla podle typu práce. V oboru, kde záleží na barvách a detailech, to ocení každý pracovník. Svítidla mají delší životnost, jsou prachotěsná a téměř bezúdržbová. Investice se společnosti vrátí během dvou let.



V REDA
● rychlá návratnost investice do 2 let
● instalace až ve výšce 16 metrů
● bez zásahu do původních rozvodů

● lepší podmínky pro práci s barvami a detaily

GUMOTEX: ROZSÁHLÁ
MODERNIZACE VE DVOU ZÁVODECH
Velký projekt modernizace proběhl také v GUMOTEXu. V Břeclavi a Jaroměři se během tří a půl měsíce vyměnila osvětlení ve čtyřech halách. Nešlo jen o hlavní světla, ale i o nouzové a antipanické systémy. Součástí projektu byly také nové rozvaděče, kabeláž a v Jaroměři dokonce svítidla reagující na pohyb vysokozdvižného vozíku.
Práce se přitom dělaly za plného třísměnného provozu, aby výroba nemusela stát. Montáže probíhaly částečně o víkendech a během přestávek.
Modernizace snížila spotřebu elektřiny na svícení skoro o sedmdesát procent. V penězích to znamená úsporu v řádu několika milionů korun každý rok. Celková investice byla devět milionů korun a návratnost je tak velmi rychlá.














PROJEKTŮ










Tři rozdílné projekty, tři různé výzvy, ale stejný výsledek: modernizace osvětlení přináší průmyslovým firmám úspory v desítkách procent, zlepšení pracovních podmínek a vyšší spolehlivost provozu.


REDA vsadila na rychlé řešení bez odstávky, BRUSH zvládl instalaci ve výšce téměř čtyřicet metrů a GUMOTEX realizoval jednu z nejrozsáhlejších výměn v tuzemsku. Všechny příklady ukazují, že dobře navržený projekt se vrátí nejen v číslech na fakturách za energie, ale i v každodenní spokojenosti lidí na pracovišti



Bezvýkresová výroba představuje zásadní posun v tom, jak firmy přistupují k technické dokumentaci, výrobní přípravě a komunikaci mezi konstrukcí, výrobou a kontrolou kvality. Místo tradičních výkresů se využívají plně digitální 3D modely, které obsahují geometrii, toleranční značky, poznámky k výrobě i informace pro kontrolní procesy. Tento přístup umožňuje přímé propojení konstrukčních dat s výrobními systémy bez nutnosti interpretace nebo převodu do papírové podoby.
Příklady z automobilového průmyslu
V automobilovém průmyslu se bezvýkresová výroba již prakticky stala standardem. Společnost BMW například využívá tzv. model-based definition (MBD) v rámci svých PLM systémů. Díky tomu může výrobní oddělení pracovat přímo s 3D daty bez nutnosti generovat výkresy. CNC stroje, robotická pracoviště i měřicí systémy načítají data přímo z modelu, což zkracuje čas přípravy výroby a snižuje riziko chyb způsobených nesprávnou interpretací výkresové dokumentace..
Výhody digitální kontinuity
Významným přínosem je také zajištění konzistence dat napříč celým životním cyklem produktu. Digitální model je jediným zdrojem informací, který se využívá od návrhu přes výrobu až po servis. To umožňuje sledovat změny, provádět simulace a optimalizovat procesy bez nutnosti ručního přepisování nebo aktualizace výkresů.
Podmínky úspěšné implementace
Úspěšná implementace bezvýkresové výroby vyžaduje standardizaci datových struktur, kompatibilitu mezi CAD, CAM a ERP systémy a především změnu pracovních návyků.
Výrobní pracovníci, technologové i kontrolní technici musí být schopni pracovat s digitálními modely a chápat jejich strukturu. To klade nároky na školení, metodiku a systémovou podporu.











































































































































































Zkušenosti z leteckého průmyslu
V oblasti letectví je bezvýkresová výroba rovněž běžnou praxí. Boeing již v roce 2012 oznámil, že u některých programů přechází na výhradní použití MBD. Výsledkem bylo snížení počtu změnových požadavků, zrychlení výroby a lepší sledovatelnost dat. Podobný přístup dnes uplatňují i dodavatelé v oblasti přesného strojírenství, kde je důraz na toleranční analýzu a kontrolu geometrie zásadní.
Bezvýkresová výroba jako součást digitalizace
Bezvýkresová výroba není pouze technologickým trendem, ale logickým krokem v rámci digitalizace průmyslu. Firmy, které ji dokáží efektivně implementovat, získávají výhodu v podobě rychlejšího vývoje, flexibilní výroby a snížení nákladů na dokumentaci. V kombinaci s digitálním dvojčetem, automatizovanou kontrolou a datovou integrací představuje tento přístup základ moderního výrobního inženýrství.



































Pomůžeme vaší firmě růst díky špičkovým technologiím a dlouholetým zkušenostem s implementací oborového ERP řešení.
Kontaktujte nás pro více informací a začněte transformovat svou výrobu.























Chytré továrny nejsou vzdálenou vizí budoucnosti. Už dnes představují zásadní transformační sílu průmyslu. Mění způsob, jakým firmy plánují, vyrábějí, vyhodnocují a optimalizují své procesy. Chytrá továrna je místo, kde spolu stroje, systémy i lidé mluví digitální řečí a data pomáhají dělat lepší rozhodnutí.
Smart factory je digitálně propojené výrobní prostředí, v němž stroje, zařízení i lidé sdílejí data v reálném čase, aby se výroba automaticky optimalizovala. Jde o implementaci zásad Průmyslu 4.0, propojené infrastruktury, cyklické analýzy dat, umělé inteligence a IoT (Internet of Things).
Tyto továrny mají schopnost samostatně upravovat výrobní tok, detekovat poruchy a měnit výrobní postup podle přetížení nebo poptávky. Technologie zahrnují chytré senzory, robotiku, strojové učení, cloudové služby a digitální dvojčata, tedy virtuální repliky fyzických systémů pro simulace a predikce.
Chytré továrny mění způsob, jakým přemýšlíme o výrobě, plánování i kvalitě. Díky propojeným technologiím, digitalizaci a využití dat v reálném čase přinášejí hmatatelné zlepšení v mnoha oblastech:
Méně chyb, více výkonu. Automatizace výrobních kroků, propojení strojů do jednoho systému a kontrola kvality na základě senzorických a kamerových dat snižují lidské i systémové chyby. Systém sám upozorní na odchylku ještě dříve, než by si jí všiml pracovník. Díky tomu se daří snížit zmetkovitost o desítky procent a zvýšit celkovou výtěžnost výroby, podle některých dat až o 20 %.
Například při výrobě dílů pro automobilový průmysl je možné v reálném čase sledovat, zda každý kus odpovídá předem stanoveným parametrům. Pokud ne, systém jej automaticky vyřadí nebo navrhne korekci nastavení strojů.
Údržba, která ví, co se stane zítra Prediktivní údržba je jedním z největších přínosů chytrých továren. Díky sběru dat ze senzorů přímo ze strojů je možné předpovídat jejich opotřebení a plánovat údržbu v době, kdy je to nejvhodnější, tedy ještě předtím, než dojde k poruše.
Namísto náhlých výpadků, které ochromí výrobu, se provádějí zásahy preventivně a s minimálním dopadem na provoz.
Výsledkem je nižší počet odstávek, delší životnost zařízení a lepší využití kapacity strojů.
Výroba, která se umí přizpůsobit. Změny v poptávce, zkracující se životní cyklus produktů a rostoucí tlak na individualizaci kladou na výrobce nové nároky.
Chytrá továrna se těmto změnám dokáže přizpůsobit téměř v reálném čase.
Flexibilita se opírá o modulární výrobní linky, roboty s nastavitelnými programy a softwarové modely, které umožňují měnit výrobní postupy bez nutnosti rozsáhlé přestavby. Výroba jednoho typu výrobku může být rychle přesměrována na jiný, například když se změní objednávky nebo se objeví nové specifikace od zákazníka.

Úspory, které dávají smysl. Propojené systémy v chytrých továrnách vedou k lepšímu využití surovin, energie i lidské práce. Výsledkem jsou úspory, které se promítají nejen do hospodářských výsledků firmy, ale i do jejího dopadu na životní prostředí.
Systémy dokážou optimalizovat spotřebu elektřiny podle momentálního zatížení, eliminovat plýtvání materiálem díky přesné dávkovací technice a efektivně plánovat směny i pohyb zásob. Tyto úspory jsou dobře měřitelné. Výrobní podniky často uvádějí snížení spotřeby energií o 15 až 30 % a zkrácení času výroby o více než pětinu.
Moderní chytré továrny jsou postavené na propojení několika klíčových technologií, které umožňují pružnou, úspornou a prediktivní výrobu. Jejich integrace vytváří digitální ekosystém, v němž se fyzické a virtuální prostředí plynule doplňují.
Internet věcí a průmyslový IoT
Základem každé chytré továrny je schopnost sbírat a sdílet data. Síť senzorů a zařízení připojených k internetu umožňuje sledovat stav výroby v reálném čase. Senzory zaznamenávají teploty, vibrace, vlhkost, tlak nebo průtok materiálu a přenášejí tyto informace do




centrálního systému, kde jsou dále vyhodnocovány. Průmyslový IoT rozšiřuje tuto schopnost o komunikaci mezi jednotlivými zařízeními a umožňuje decentralizované řízení výroby.
Umělá inteligence a strojové učení
Umělá inteligence představuje mozek chytré továrny. Učí se z historických dat i provozních situací, navrhuje efektivnější strategie řízení a předpovídá poruchy ještě předtím, než nastanou. Díky strojovému učení je možné v reálném čase detekovat výrobní odchylky, rozpoznávat vady na základě kamerových záznamů nebo optimalizovat trasu autonomních vozíků. Systémy se průběžně přizpůsobují provozu bez nutnosti zásahu programátora.
Digitální dvojče je virtuální model skutečného zařízení nebo celého výrobního procesu. Slouží ke sledování a simulaci chování strojů v reálném čase, a to s využitím dat ze senzorů a analytických nástrojů. Výrobce tak může ještě před fyzickou změnou ověřit efektivitu nové konfigurace, posoudit dopady na kvalitu nebo identifikovat potenciální rizika. Tato metoda je využívána například při vývoji turbín, výrobních linek nebo energetických systémů.
Edge computing
Při řízení citlivých operací nestačí posílat všechna data do cloudu. Edge computing zajišťuje okamžité zpracování přímo na místě, v zařízení nebo řídicím modulu. Díky tomu mohou stroje reagovat na výkyvy v milisekundách a upravovat parametry operace ještě během výroby. To je zásadní například u obráběcích strojů, kde je nutná vysoká přesnost a rychlá zpětná vazba.
Pátá generace mobilních sítí
5G připojení umožňuje extrémně rychlý přenos dat s nízkou latencí. Tím se stává nezbytným nástrojem pro provoz bezdrátových továren, ve kterých jsou roboti, vozíky a senzory v neustálé komunikaci bez fyzické kabeláže. Tento přístup usnadňuje reorganizaci výroby, přestavbu layoutu nebo zavádění mobilních jednotek bez rozsáhlých stavebních úprav.
Robotika a kolaborativní roboti
Moderní roboty už nejsou omezeny na uzavřené prostory a jednotvárné činnosti. Díky pokročilým bezpečnostním funkcím mohou kolaborativní roboti pracovat přímo vedle člověka. Pomáhají s opakovanými nebo ergonomicky náročnými úkoly a přizpůsobují se různým produktům i pracovním rytmům. Díky snadnému programování je lze nasadit během několika hodin.
Spojte se s našimi experty pro osobní konzultaci a zjistěte, jak může MCP – PLAY posílit právě Vaše podnikání.


Modulární dopravníková platforma (MCP) se posouvá na novou úroveň – do podoby MCP - PLAY, která je chytřejší než kdy dříve!
Hlavní přínosy:
• Rychlejší instalace, zprovoznění a uvedení do provozu pro rychlejší realizaci projektů.
• Vyšší úspora elektrické energie z důvodu optimalizovaného provozu.
• Nižší nároky na programování a uvedení do provozu –úspora času a zdrojů.
• Snížené náklady na údržbu a prodloužená životnost systému.
• Intuitivní softwarové nástroje přináší zjednodušený layout design.
• Minimální potřeba pokročilých programátorských znalostí snižující požadavky na personál.
• Snadná integrace s minimálním narušením provozu.
Kontakt: Tel.: +420 777 256 258 - E-mail: j.lebloch@interroll.com






MES systémy a pokročilá automatizace
Manufacturing Execution Systems propojují plánování výroby s reálným provozem. Sledují tok materiálu, průběh zakázek, kontrolu kvality i nasazení pracovníků. V chytré továrně tak rozhodují data, nikoliv odhady. Systém navíc okamžitě upozorní na odchylku, umožní optimalizaci nebo přepnutí na jiný výrobek bez nutnosti výměny celé linky.
Jak vypadá chytrá továrna v reálném světě?
Siemens Amberg a Bosch Rexroth (Německo)
Továrna Siemens v Ambergu bývá často označována jako učebnicový příklad chytré výroby. Už více než dekádu zde funguje propojený
ekosystém senzorů, softwaru a systémů řízení, který dokáže sledovat až 50 milionů procesních dat denně. Díky nasazení umělé inteligence a strojového učení se data nejen sbírají, ale i okamžitě vyhodnocují a slouží k prediktivnímu řízení výroby. Výsledkem je bezprecedentní kvalita. Chybovost na úrovni 11 vad na milion produktů.
Bosch Rexroth zase vyvíjí a implementuje řešení v duchu tzv. „Industry 4.0-ready“ linek. Jejich montážní systémy jsou modulární, plně digitálně řízené a využívají kolaborativní roboty, kteří bez ochranných klecí spolupracují s operátory. Výrobní procesy se tak dají během jednoho dne přestavět na nový typ výrobku bez nutnosti měnit infrastrukturu.
General Electric (USA)
GE přistoupil k digitální transformaci s globálním rozsahem. V rámci konceptu „Brilliant
Factories“ využívá internet věcí (IoT), prediktivní analytiku a digitální dvojčata k tomu, aby dokázal v reálném čase sledovat výkonnost strojů, předcházet poruchám a optimalizovat procesy napříč pobočkami. V jedné z továren GE v Indii došlo po zavedení těchto technologií ke snížení neplánovaných prostojů o 20 %, zatímco efektivita výroby stoupla o 18 %.
Florasis (Čína)
Značka Florasis představuje novou vlnu digitalizace i v kosmetickém průmyslu. Jejich továrna v čínském Hangzhou funguje jako „smart brain“, tedy centrální mozek řízený umělou inteligencí. AI systém řídí nejen kvalitu výroby, ale i energetický management, přičemž solární panely na
















TŘI TESTBEDY (TESTOVACÍ PROSTŘEDÍ) PRŮMYSLU 4.0
INFRASTRUKTURA PRO VÝZKUM
A IMPLEMENTACI DIGITÁLNÍCH TECHNOLOGIÍ, ROBOTIKY
A AUTOMATIZACE.
44 % ČESKÝCH STROJÍRENSKÝCH
FIREM ZAVEDLO AUTOMATIZACI, U FIREM S MEZINÁRODNÍM DOSAHEM
JE TO 68 %.
15 % PODNIKŮ AKTIVNĚ
IMPLEMENTUJE DIGITALIZACI. 20 % SE DIGITALIZACÍ VŮBEC NEZABÝVÁ.
DIGITÁLNÍ DVOJČATA PODPORUJÍ OPTIMALIZACI, PŘEDVÍDÁNÍ A EFEKTIVNÍ PROVOZ CHYTRÉ VÝROBY.
Xiaomi „dark factory“ (Čína)
Xiaomi svou továrnou bez lidské obsluhy posunulo koncept chytré továrny do extrému. V tzv. „dark factory“ není potřeba svítit, protože tu nepracují lidé. Výroba běží 24 hodin denně, 7 dní v týdnu, s minimální potřebou lidského zásahu. Celý proces, od osazení čipů po finální zabalení chytrého telefonu, je řízen interně vyvinutým AI systémem, který zajišťuje nejen koordinaci robotů, ale i kontrolu kvality a správu zásob. Jediný chybný pohyb v celém řetězci spustí automatickou reakci systému a opravu.
Zatímco dříve se koncept chytré výroby spojoval především s Německem, Japonskem nebo Spojenými státy, dnes se s úspěchem rozvíjí také v České republice. Firmy, univerzity i výzkumná centra investují do moderních řešení a reálných projektů, které mají měřitelné výsledky a pozitivní dopad na průmyslovou konkurenceschopnost.

► CEITEC Testbed v Brně
Jedním z nejpokročilejších projektů v oblasti Průmyslu 4.0 v České republice je Testbed for Industry 4.0 na CEITEC VUT v Brně. Tento experimentální prostor, otevřený v roce 2022 za podpory Evropské unie a s investicí kolem 450 milionů korun, umožňuje testování a zavádění digitálních technologií v reálných podmínkách. Malé a střední podniky si zde mohou vyzkoušet například implementaci senzorů, robotizovaných linek, prediktivní údržby nebo autonomní logistiky. Cílem je zrychlit digitalizaci českého průmyslu a usnadnit přístup k inovacím i mimo velké korporace.
► ŠKODA TRANSPORTATION
A DIGITÁLNÍ DVOJČATA
V Plzni a Ostravě se skupina Škoda Transportation intenzivně zaměřuje na vývoj chytré výroby kolejových vozidel. Firma investuje do digitalizace procesů a využití digitálních dvojčat při výrobě vozových skříní, podvozků a dalších komponent. Pomocí simulačních




10+ VÝZKUMNÝCH CENTER A UNIVERZIT SE PODÍLÍ NA VÝVOJI CHYTRÝCH VÝROBNÍCH ŘEŠENÍ (TUL, CIIRC, VŠB-TUO, CEITEC, ZČU, VUT, ČVUT, UTB…)
30+ PRŮMYSLOVÝCH FIREM V ČR SPOLUPRACUJE NA DIGITALIZACI VÝROBY A ZAVÁDĚNÍ CHYTRÝCH TECHNOLOGIÍ (NAPŘ. BOSCH, SIEMENS, ŠKODA TRANSPORTATION, CONTINENTAL…)

STOVKY STUDENTŮ ROČNĚ







ZÍSKÁVAJÍ PRAKTICKOU ZKUŠENOST S PRŮMYSLEM 4.0. DÍKY PROJEKTŮM V TESTBEDECH, SIMULACÍM, ROBOTICKÝM SOUTĚŽÍM A PRŮMYSLOVÝM STÁŽÍ.











8+ AKTIVNÍCH TESTBEDŮ V ČR, KDE SE TESTUJÍ PRVKY DIGITÁLNÍ VÝROBY, EDGE COMPUTINGU, PREDIKTIVNÍ ÚDRŽBY ČI AUTONOMNÍ LOGISTIKY.







modelů a senzorických dat lze předem vyhodnocovat chování produktů v provozu a optimalizovat výrobní parametry. Výsledkem je nejen vyšší kvalita, ale i rychlejší reakce na potřeby zákazníků.
► AŽD PRAHA A AUTONOMNÍ VLAK
Inovace zasahuje i do železniční dopravy. Společnost AŽD Praha v roce 2021 představila první autonomní vlak v České republice. Jezdí na trati mezi Kopidlnem a Dolním Bousovem a využívá systémy automatického řízení bez nutnosti lidské obsluhy. Od roku 2025 má být tento provoz plně komerční. Integrace kamer, senzorů, IoT komunikace a umělé inteligence zde slouží nejen ke zvýšení bezpečnosti, ale i k optimalizaci jízdních řádů a provozních nákladů.
► OSTRAVSKÁ LABORATOŘ PRŮMYSLU 4.0
Na Vysoké škole báňské – Technické univerzitě Ostrava vznikla laboratoř Průmyslu 4.0, která propojuje výuku, výzkum a praxi. Studenti zde pracují s modulární výrobní linkou, která je postavená na stavebnici Lega, ale obsahuje všechny klíčové prvky reálné výroby – senzory, programovatelné automaty, dálkové řízení i dato-





vou analytiku. Cílem je přiblížit principy chytré výroby nejen odborníkům, ale i širší veřejnosti a motivovat budoucí inženýry k vývoji nových řešení.
► DIGITÁLNÍ TRANSFORMACE V NÁBYTKÁŘSTVÍ
Technologie chytrých továren se objevují i v tradičních odvětvích. V českém nábytkářství dochází k masivnímu nasazení senzorů, analytických nástrojů a automatizace. Firmy, které vsadily na digitalizaci výroby, dosahují podle dostupných údajů zvýšení efektivity až o padesát procent během pěti let. Přínosy jsou patrné zejména v oblasti plánování výroby, řízení zásob a úspory materiálu.
► NÁRODNÍ CENTRUM PRŮMYSLU 4.0
Kromě jednotlivých podniků a výzkumných institucí sehrává důležitou roli i systémová podpora. Národní centrum Průmyslu 4.0 propojuje firmy, univerzity a veřejné instituce s cílem urychlit digitální transformaci průmyslu. Vznikají mapy technologických kompetencí, síť sdílených testbedů a metodiky pro zavádění pokročilých řešení i v malých výrobních podnicích. Důležité je, že tato centra nejsou jen















teoretickým prostorem, ale fungují jako praktický most mezi vědou, firmami a každodenní výrobou.
Chytré továrny už nejsou experimentem nebo vizí z PowerPointových prezentací. Stávají se skutečným pilířem průmyslové konkurenceschopnosti, ať už jde o automobilky, strojírenské závody, logistická centra nebo nábytkářské dílny. Nejde jen o technologii, ale především o nový způsob myšlení.
O odvahu testovat, integrovat a učit se ze zpětné vazby v reálném čase.České firmy, výzkumné instituce i startupy se v tomto směru rozhodně neztratí. Mnohé z nich už dokazují, že ani omezené rozpočty nebo velikost podniku nejsou překážkou. Díky sdíleným testbedům, partnerským sítím a otevřenému přístupu k inovacím je možné začít i s menšími kroky, které ale v součtu znamenají velký posun.
Digitalizace výroby, nasazení umělé inteligence, schopnost předvídat, plánovat a přizpůsobovat se, to všechno se stává běžnou součástí průmyslového prostředí. V konečném důsledku tak chytrá továrna není o robotech místo lidí. Je o lepší spolupráci mezi lidmi a technologiemi. A právě v tom je její síla.
Automatizace s Murrelektronik
Fenomika rostlin zkoumá, jak genetická výbava ovlivňuje vlastnosti rostlin. V Centru fenomiky rostlin v Lublinu vědci testují odolnost rostlin vůči stresu, suchu či škůdcům pomocí spektrálních kamer a senzorů, které v reálném čase sledují fyziologické parametry. Cílem je získat data pro udržitelnější a efektivnější zemědělství.
Pro takový výzkum vznikla unikátní fenotypizační linka od české společnosti Photon Systems Instruments (PSI), spuštěná v roce 2022. Kombinuje dopravníky, senzory, kamery i růstové komory a umožňuje simulaci specifických podmínek včetně tmy či specifického spektra světla. Výhodou je i možnost vzdáleného řízení a zálohování dat.
Zásadní roli v provozu linky hrají komponenty Murrelektronik. Robustní EtherCAT kabely zajišťují přesný sběr dat, panelové průchodky M12 s krytím IP67 garantují spolehlivost i v náročných podmínkách. Napájení obstarávají zdroje Emparro s režimem HyperBoost a UPS moduly chrání data při výpadku proudu.
PSI ocenila nejen kvalitu produktů, ale i rychlý servis a dodávky i v době pandemie.

Neříkám, že jsou jedinou volbou. Ale z naší zkušenosti jsou tou nejlepší.
Michal Štys z PSI
Použité komponenty Murrelektronik
● EtherCAT kabely –robustní, přesný přenos dat, odolnost proti rušení
● Panelové průchodky M12 (IP67) – spolehlivost i v náročných podmínkách
● Napájecí zdroje Emparro Advanced – režim HyperBoost pro okamžité navýšení výkonu

● UPS moduly – ochrana dat při výpadku proudu










TISÍCE FIREM ČEKÁ NOVÝ REŽIM
Ve čtvrtek 26. června 2025 podepsal prezident ČR dlouho očekávaný nový zákon o kybernetické bezpečnosti (dále jen „NZKB“). Formální zveřejnění NZKB ve Sbírce zákonů by mělo proběhnout během srpna, přičemž lze předpokládat, že norma nabude účinnosti počátkem listopadu 2025.
NZKB transponuje do českého právního řádu požadavky evropské směrnice NIS2 (Směrnice Evropského parlamentu a Rady (EU) 2022/2555 ze dne 14. prosince 2022 o opatřeních k zajištění vysoké společné úrovně kybernetické bezpečnosti v Unii), jejímž účelem je rozšířit dosavadní okruh regulovaných odvětví a služeb.
Účinností NZKB se budou povinnosti v oblasti kyberbezpečnosti nově vztahovat na tisíce sub-
jektů, které doposud stály mimo regulatorní perimetr. Stejně jako každá nová právní úprava bude i NZKB klást nové požadavky a tím vytvářet zvýšenou odpovědnost pro manažery dotčených společností.
Nová právní regulace kyberbezpečnosti navazuje na nařízení DORA (nařízení Evropského parlamentu a Rady (EU) 2022/2554 ze dne 14. prosince 2022 o digitální provozní odolnosti finančního sektoru), které začalo být přímo aplikovatelné od 17. ledna 2025. Zmíněné nařízení ovšem pokrývá kybernetickou bezpečnost a provozní odolnost specificky pro finanční sektor. Členské státy měly směrnici






NIS2 transponovat do 17. října 2024, NZKB tedy přichází zhruba s ročním zpožděním.
Návrh zákona a související vyhlášky vznikly pod taktovkou Národního úřadu pro kybernetickou a informační bezpečnost (dále jen „NÚKIB“). NÚKIB při přípravě NZKB vycházel vedle samotné směrnice NIS2 také z původního zákona o kybernetické bezpečnosti (zákon č. 181/2014 Sb., o kybernetické bezpečnosti a o změně souvisejících zákonů, ve znění pozdějších předpisů) a z praktických zkušeností a řešení reálných incidentů ze své letité praxe. NÚKIB současně působí jako obecný dozorový orgán pro kyberbezpečnost a bude ji nadále vykonávat i v režimu NZKB.
Směrnice NIS2 představuje nový minimální unijní standard (tzv. „minimum-rule“) pro kybernetickou bezpečnost v členských státech EU, jedná se tedy o minimální harmonizaci, kdy si členské státy mohou stanovit přísnější pravidla, ale nikoliv mírnější než ta v harmonizované normě. NIS2 nahrazuje původní sektorově užší směrnici NIS z roku 2016 (Network and Information Security Directive) a podstatně rozšiřuje osobní působnost regulace: pravidla se nově budou vztahovat na osmnáct odvětví.
Vedle původních odvětví dle NIS (energetiky, zdravotnictví, dopravy, vodohospodářství, digitální infrastruktury, poskytovatelů řízených ICT služeb, infrastruktury finančních trhů a bankovnictví) se přidávají například veřejná správa, potravinářství, vesmír, poštovní služby, chemický průmysl či řízené IT služby. Z digitálních služeb dopadne NIS2 například na poskytovatele softwarových služeb, provozovatele cloudových úložišť a datacenter, na online platformy včetně e-tržišť a rovněž na firmy, které nabízejí řízené IT či bezpečnostní služby.
Aby byla zaručena přiměřenost požadavků, směrnice zavádí dvě kategorie regulovaných subjektů:
→„essential entities“ jsou organizace, které plní klíčovou roli pro fungování společnosti a hospodářství
→„important entities“ zahrnují středně velké podniky, jejichž výpadek by rovněž mohl mít významný dopad.
Všechny regulované subjekty (essential i important) musejí mít formálně schválenou a pravidelně aktualizovanou politiku kybernetické bezpečnosti, která pokrývá řízení rizik, bezpečnost dodavatelského řetězce, vícefaktorové ověřování a řízení přístupů, systematické zálohování/obnovu dat a procesy reakce na incidenty a další. NIS2 současně značně posiluje dozorové mechanismy. Dozorové orgány mohou v režimu NIS2 uložit vysoké pokuty.
Pro vrcholové vedení organizací je klíčovou novinkou i to, že členové statutárních orgánů mohou být v krajním případě dočasně zbaveni možnosti vykonávat svou funkci.
Česká právní úprava je v tomto ohledu poměrně detailní a přísná. NZKB zavádí nástroj dočasného zákazu výkonu funkce člena statutárního orgánu u poskytovatelů regulovaných služeb v režimu vyšších povinností (tzv. essential entities). NÚKIB může tento zákaz uložit, jestliže člen orgánu opakovaně nebo závažně poruší své povinnosti při naplňování protiopatření NÚKIB, a tím znemožní řádné odstranění zjištěných nedostatků. Sankce trvá nejméně šest měsíců a končí teprve poté, co jsou pochybení prokazatelně napravena. Toto opatření se vztahuje výhradně na soukromoprávní funkce, nikoli na veřejné mandáty obsazované volbou či jmenováním. Pokud je statutárním členem právnická osoba, zákaz dopadá i na fyzickou osobu, která ji při výkonu funkce zastupuje. Rozhodnutí o zákazu i o jeho zrušení se bezodkladně zapisují do obchodního rejstříku a zároveň se zveřejňují na webu NÚKIB, čímž získávají veřejnou povahu a reputační dopad. Odvolání (rozklad) proti tomuto rozhodnutí nemá odkladný účinek, takže sankce nabývá účinnosti okamžitě
Kybernetická bezpečnost již tedy nebude starostí jen IT oddělení. Členové řídících orgánů jsou povinni absolvovat odborná školení, aby získali potřebné znalosti k porozumění rizikům a jejich efektivnímu řízení. Kombinace
finančních a osobních sankcí má značně motivovat management regulovaných subjektů, aby kybernetickou bezpečnost vnímal jako otázku strategického řízení, nikoli jen technickou záležitost.
NZKB tedy formuluje minimální povinnou úroveň kybernetického zabezpečení v organizacích působících v hospodářsky, společensky či bezpečnostně významných odvětvích splňujících stanovená kritéria. Vzhledem k tomu, že směrnice NIS2 rozšiřuje seznam regulovaných odvětví a služeb, dopadne nový zákon na výrazně širší okruh subjektů, odhadem v řádech několika tisíců nově regulovaných subjektů v rámci ČR (cca 5 000 – 6 000 subjektů).
Některé sektory jsou v NZKB na rozdíl od NIS2 vymezeny mírně odlišně, či byly doplněny o další oblasti, aby regulace lépe korespondovala s lokálními potřebami a již existující legislativou.
SUBJEKTY DLE
NZKB SPLNIT?
Jakmile organizace spadne do působnosti zákona a je považována za regulovaný subjekt,
čeká ji několik základních povinností v rozsahu vyššího (essential entity) či nižšího (important entity) režimu dohledu.
Jedná se ve stručnosti o následující postup:
Ohlášení služby – formální registrace služby, kterou organizace poskytuje – každá společnost zařazená do kategorie essential či important entity musí provést povinný self-assesment a do tří měsíců od účinnosti NZKB vyplnit elektronický dotazník NÚKIB (do budoucna do 60 dní od naplnění znaků regulovaného subjektu), kterým se organizace sama zapíše do registru regulovaných subjektů. Posouzení vychází z počtu zaměstnanců, výše ročního obratu a sektorového zařazení. Pokud podnik uvede zkreslené údaje, může NÚKIB z moci úřední zahájit kontrolu a uložit pokutu až 250 mil. Kč;
Úprava vnitřních předpisů – po dokončení self-assesmentu (pokud se samozřejmě jedná o regulovaný subjekt) musí organizace aktualizovat interní předpisy: formálně schválit bezpečnostní politiku, zavést proces řízení rizik a registr ICT aktiv, zajistit každoroční audit souladu provedený akreditovaným auditorem a doplnit dodavatelské smlouvy o požadavky NIS2 na bezpečnost řetězce – konkrétní kritéria výběru a bezpečnostní požadavky musí být nově zakotveny ve smlouvách s dodavateli;
Nahlášení kontaktních osob – předání údajů o pracovnících odpovědných za kybernetickou bezpečnost;
Postupné zavádění bezpečnostních opatření – technická i organizační opatření dle vyhlášek pro příslušný režim například ve formě kontroly přístupů a nutné silné autentizace, kryptografie
a šifrování apod., kyberhygiena a pravidelná školení a další;
Hlášení incidentů – povinnost oznamovat kybernetické bezpečnostní incidenty v předepsaných lhůtách, zde vznikne v praxi často dvojí povinnost hlásit incident v případě incidentů podléhajících rovněž GDPR, je tedy třeba sladit vnitřní předpisy i v tomto ohledu;
Plnění protiopatření NÚKIB – realizace závazných pokynů NÚKIB v roli dozorového orgánu při závažných hrozbách, protiopatření jsou ve formě výstrahy, varování a následně retroaktivního opatření, které organizace musí splnit. Při nedodržování povinností může být z rozhodnutí NÚKIB pozastavena certifikace regulovaného subjektu, či jak již bylo zmíněno, stanoven dočasný zákaz výkonu funkce statutárního orgánu pro vedení organizace;
Sankce – NZKB stanovuje sankce za nesplnění výše indikovaných povinností až do výše 250.000.000,- Kč nebo 2 % z čistého celosvětového obratu pro essential entities a 175.000.000,- Kč nebo 1,4 % z čistého celosvětového obratu pro important entities, přičemž pokuta se vždy počítá z částky, která je vyšší.

Nová česká právní úprava kyberbezpečnosti ve formě NZKB sice teprve vstupuje do života, ale přípravy jsou určitě na místě. Self-assesment a registrace stanovují první klíčový termín, přičemž jeho nedodržení může vaši organizaci vystavit vysokým pokutám ještě před jakýmkoli kybernetickým incidentem. Nová právní úprava současně zásadně posouvá těžiště odpovědnosti přímo na nejvyšší úroveň řízení. Tím, že klade jasné povinnosti a sankční mechanismy právě na management, vytváří silný motivační tlak k aktivnímu řízení kybernetické bezpečnosti, nikoliv pouze po formální stránce, ale jako strategickou prioritu.
Regulační rámec si neklade za cíl organizace trestat, nýbrž je připravit na reálné kybernetické hrozby v době raketového technologického rozvoje. Důsledná implementace požadovaných opatření nepřináší jen formální splnění právních povinností, ale především výrazně zvyšuje odolnost vůči útokům, posiluje důvěru zákazníků i obchodních partnerů.
V případě jakýchkoli dotazů k tématu právní regulace kyberbezpečnosti či dalším oblastem EU regulace a compliance jsme Vám v PEYTON legal k dispozici.









Mgr. Martin Heinzel, partner heinzel@plegal.cz
JUDr. Tereza Pechová advokátní koncipientka pechova@plegal.cz








Provozovatelé zdvihacích zařízení v České republice musí plnit relativně přísné legislativní podmínky. Výhodnou cestou, jak nejen splnit požadavky zákona, ale také udržet dlouhodobou spolehlivost jeřábu, je svěřit jej plně do kompetence jednoho zkušeného dodavatele: firmy Konecranes.

Finská firma Konecranes pokračuje v úspěšném tažení na jeřábovém trhu v České republice. Těží zejména ze svého know-how, které se ve firmě buduje již od roku 1930. V České republice Konecranes působí od 90. let. Konecranes má v České republice respektovanou výrobu standardních i procesních jeřábů a obchodně se jí mimořádně daří. Dále se ale zaměříme zejména na služby, které Konecranes nabízí svým zákazníkům. V oblasti servisu jeřábů totiž dosáhla u nás tato firma naprosto jedinečného postavení, díky komplexnímu přístupu ke zdvihacím zařízením v průběhu celého jejich životního cyklu.
NEPŘÍJEMNÁ POVINNOST SE STALA PŘÍLEŽITOSTÍ
„Celá desetiletí se servisu jeřábů a zdvihacích zařízení v České republice nikdo systematicky nevěnoval. Většina firem se zákonnou povinnost revizí snaží naplnit jen v nejnutnější možné míře,“ vysvětluje Lukáš Rosenberg, obchodní manažer Konecranes pro Českou a Slovenskou republiku. Když tým pana Rosenberga začal

prosazovat péči o jeřáby po celou dobu jejich životnosti a proaktivní přístup k servisu, společnost se v tomto u nás stala průkopníkem. „Prvních 6 let jsme nedělali nic jiného, než edukovali uživatele jeřábů v péči o ně. A pravda je taková, že vzdělávání je klíčovou součástí naší činnosti dodnes. To, že jsme byli první, mělo ale své výhody. Moderně uvažující ředitelé firem pochopili, kudy se svět ubírá, a využili výhod servisní smlouvy, díky kterým se mohou věnovat své výrobě a zodpovědnost za jeřáby nechat na nás,“ shrnuje Lukáš Rosenberg.
VYŘEŠIT SERVIS JEDNOU PROVŽDY
Konecranes je silný partner, který dokáže nejen dodat jeřábovou techniku, ale také zajistit pro své zákazníky servis všech jejich průmyslových jeřábů. A to s garancí včasných dojezdů techniků a dodání náhradních dílů podle uzavřených smluv. Konecranes se skutečně postará o servis jakékoliv značky jeřábu a převezme za něj zodpovědnost. Co vedlo k tomuto kroku, upřesňuje pan Rosenberg: „Snažíme se usnadnit práci našim partnerům a nechceme to dělat
polovičatě. Máme znalosti i zdroje k tomu být jediným dodavatelem všech služeb a zařízení pro jeřábovou techniku. Konecranes ve světě vlastní řadu dalších značek jeřábů, takže technicky nevím o zařízení, s nímž bychom si neporadili. Za posledních osm let počet našich techniků několikanásobně vzrostl a máme střediska po celé republice. Spolupráce s námi je výhodná i kvůli tomu, že většina velkých výrobců je nucena držet jen omezený počet dodavatelů, a od nás získají všechny produkty i služby, které pro své spolehlivé a bezpečné zdvihání potřebují.“
Konecranes působí v 55 zemích světa a patří mezi tři největší výrobce jeřábů na naší planetě. Akvizicí firmy Demag před několika lety získal dominantní postavení v Evropě i nové zdroje znalostí a zkušeností. Součástí korporace jsou také firmy R&M, SWF Krantechnik, Verlinde nebo Donati. V České republice je servis samostatnou jednotkou, nezávislou na výrobě a prodeji mostových
jeřábů, plně soustředěný na péči o zákazníky. V současnosti má servis 63 zaměstnanců a příští rok bude Konecranes opět několik nových techniků do týmu přibírat. Hlavní servisní střediska je nacházejí ve Slaném, Ostravě a v Brně. Ostatní technici jsou rozmístěni po celé zemi „Každý technik má svoje plně vybavené služební auto s nářadím a základními náhradními díly. Samozřejmostí je telefon a počítač, bez digitální správy servisu si naši práci už ani neumíme představit,“ říká Lukáš Rosenberg a pokračuje:
„Klíčové je pro nás také školení pracovníků, aby byli schopni pracovat samostatně a maximálně efektivně. K tomu účelu jsme před rokem zřídili i tréninkové centrum v naší centrále ve Slaném.“
BEZPEČNOST NA PRVNÍM MÍSTĚ
Málokdy k servisu nastupují noví pracovníci, kteří by neměli v oboru žádné zkušenosti. Přesto si všichni projdou základním školením. Mají příležitost strávit nějaký čas ve výrobě jeřábů, kde od základu pochopí, jak co funguje.
Hlavní část jejich přípravy pak probíhá v tréninkovém centru, kde je k dispozici dvoukočkový simulátor jeřábu Konecranes a Demag a také komponenty různých dalších značek. Na nich si nováčci nacvičí rutinní operace pro práci v terénu. Každý samozřejmě musí také absolvovat řadu školení o bezpečnosti práce, požární ochraně, práci ve výškách, práci s elektrickými zařízeními a podobně. Školení neprobíhá vždy jen ve vlastních prostorách, technici také absolvují trénink na další jeřábové značky, často u konkurentů nebo distributorů těchto produktů. Tím vším vybaven pak začne nový technik doprovázet někoho ze zkušených kolegů a naučí se práci přímo u zákazníka. Heslem je vždy: Bezpečnost na prvním místě.
Po letech, kdy u nás existovaly nejasnosti v legislativě a povinnosti provozovatelů byly roztroušeny v několika zdrojích, je nyní jasno. Zákon o bezpečnosti práce v souvislosti s provozem vyhrazených technických zařízení z roku 2022 stanovuje jednoznačná pravidla. I přesto edukační práce firmy Konecranes mezi provozovateli jeřábů nekončí. „Překvapuje mě, kolik firem novou legislativu možná ani nezaregistrovalo a neobtěžovalo se reagovat reálnými opatřeními. Spoléhají se, že dokud u nich nedojde k nějakému velkému průšvihu, je to vlastně jedno,“ upozorňuje na zneklidňující situaci Lukáš Rosenberg.
V naprosté zkratce se zákon z roku 2022 týká jeřábů od 1 tuny nosnosti, stanovuje kontroly každé tři měsíce a musí je provádět pouze osoba odborně způsobilá. Opravy svépomocí jsou na těchto zařízení pak bez patřičného oprávnění zapovězené. Podle odhadů dostojí požadavkům zákona méně než polovina firem, které provozují jeřáby. Konecranes nabízí majitelům zdvihacích zařízení pomocnou ruku: „Neustále se setkávám s tím, že povědomí o zákonných pravidlech provozování jeřábů a o tom, co si ve firmě může údržba dovolit vyměnit nebo opravit, je velice slabé a pověřené osoby se v této oblasti prakticky vůbec nevzdělávají. Pokud chce mít majitel klidné spaní a spolehlivou výrobu, dokážeme převzít zodpovědnost za jeho jeřábový park a ručíme nejen za plnění zákona, ale i za spolehlivý provoz.“
Legislativní požadavky na provoz jeřáby nejsou samoúčelné. Stejně jako u servisu jakéhokoliv výrobního zařízení je smyslem hladká výroba bez neplánovaných odstávek. Péče o jeřáb po celou dobu jeho životního cyklu zajišťuje plynulý takt výroby. „Existuje řada provozů, kde jeřáb není kritické zařízení a lze jej dočasně nahradit třeba vysokozdvižnými vozíky. Máme ale zákazníky, například papírny či spalovny, kde každý den s nefunkčním jeřábem stojí firmu miliony korun,“ upozorňuje pan Rosenberg.
Smyslem zákona je především chránit zdraví lidí. Nicméně pokud se podíváme na reálné případy úrazů, prakticky vždy jsou způsobené lidským faktorem. Spojitost se zanedbáním servisu zařízení je čistě teoretická. Ve chvíli, kdy se začne nějaký incident vyšetřovat, první na řadě bude „kontrola papírů“. Podobně jako třeba u dopravní nehody. Pokud se ukáže, že zařízení nemá všechny zákonné náležitosti, vina padá na pověřenou osobu, která může být i trestně odpovědná. Také v takovém případě dochází ke krácení pojistného plnění. Nemá smysl policii nebo pojišťovně vysvětlovat, že; „Všechno bylo v pořádku, jen chybělo několik zápisů o revizi“.
Investice do servisní smlouvy je určitá forma pojištění. Majitel jeřábu si platí za jeho bezpečný a bezproblémový provoz a co nejrychlejší opravu v případě poruchy. Každá servisní smlouva je připravena na míru konkrétnímu provozovateli a může obsahovat jen jednu konkrétní činnosti nebo všech našich 25 servisních produktů pravidelné péče, včetně rychlého pohotovostního zásahu. Nejvyšší úroveň pohotovosti zaručuje, že technik firmy Konecranes dojede na místo do tří hodin od oznámení a začne pracovat na diagnostice a opravě zařízení.
V současnosti spoléhá na servis od firmy Konecranes téměř 400 smluvních partnerů. Pro 60 z nich je logistika natolik důležitá, že mají smluvně zajištěnou nepřetržitou pohotovost. „Náš přístup vychází z dlouhodobé zkušenosti. Umíme přizpůsobit naše servisní služby pro konkrétní typ výroby. Do chaosu vnášíme řád a systém, čemuž napomáhá i náš transparentní online portál, kde mají zákazníci uloženy všechny záznamy. Naši zákazníci nám potvrzují, že mít jednoho spolehlivého dodavatele pro jeřáby i jejich servis, je správná cesta k úspěchu,“ uzavírá Lukáš Rosenberg.



































Ještě před několika desetiletími byla aditivní výroba vnímána jako okrajová technologie, kterou využívaly především vývojové laboratoře a designová studia pro rychlou tvorbu prototypů. Dnes je však nedílnou součástí moderního průmyslu a přirozeně se začleňuje do výrobních procesů napříč sektory. Aditivní výroba, známá také jako 3D tisk, se vyvíjí rychlým tempem a její vliv na efektivitu, udržitelnost a technickou inovaci je čím dál výraznější.
Zatímco tradiční výrobní metody spočívají v odebírání materiálu z většího celku, aditivní přístup naopak staví objekt vrstvu po vrstvě na základě digitálního modelu. Tento způsob výroby přináší celou řadu výhod. Snižuje množství odpadu, umožňuje tvorbu složitých geometrických tvarů a přispívá k optimalizaci hmotnosti i mechanických vlastností komponent. Aditivní výroba umožňuje navrhovat díly, které by byly pomocí konvenční výroby prakticky nerealizovatelné, nebo by jejich výroba byla příliš nákladná a časově náročná.
Vývoj od prototypování k plnohodnotné výrobě
Počátky komerčního 3D tisku sahají do první poloviny osmdesátých let. V té době šlo o experimentální technologii využívající zejména fotopolymerní pryskyřice, která sloužila především k vizualizaci návrhů a tvorbě jednoduchých funkčních vzorků. Dnes už jsou však k dispozici technologie, které dokážou zpracovat širokou škálu materiálů od plastů a kompozitů až po vysoce výkonné kovy.
Současná aditivní výroba se uplatňuje nejen v oblasti vývoje a testování prototypů, ale i při malosériové a sériové výrobě. Díky rychlému vývoji tiskových technologií a neustálému zlepšování vlastností materiálů lze 3D tisk využívat i pro produkci finálních výrobků, které splňují přísné kvalitativní a bezpečnostní požadavky.
Přehled hlavních technologií
Mezi nejrozšířenější technologie 3D tisku patří metoda FDM, tedy modelování depozitem taveniny. Tento způsob využívá plastové vlákno, které je vytlačováno tryskou a ukládáno ve vrstvách. Technologie je cenově dostupná, variabilní a vhodná pro výrobu přípravků, držáků, obalových součástí nebo různých konstrukčních dílů.
Stereolitografie, známá pod zkratkou SLA, využívá k vytvrzení fotopolymerní pryskyřice ultrafialový laser. Díky vysoké přesnosti a jemnému rozlišení je ideální pro aplikace v dentální technice, šperkařství a při výrobě detailních modelů.

Metoda SLS, tedy selektivní laserové sintrování, využívá laser k tavení práškového plastového materiálu, typicky nylonu. Výsledné díly jsou mechanicky odolné, pevné a nevyžadují podpory během tisku. Její kovová varianta, označovaná jako SLM nebo DMLS, umožňuje tisk z nerezové oceli, titanu, hliníku a dalších kovů. Tyto technologie jsou běžně využívány v letectví, kosmonautice a medicíně.
Konkrétní přínosy pro průmysl
Aditivní výroba přináší výrazné zrychlení vývojového cyklu produktů. Automobilky dnes dokážou vytvořit funkční prototypy karosářských dílů v řádu dnů místo týdnů. Tím se výrazně zkracuje čas uvedení nového produktu na trh. Letectví využívá 3D tisk pro tvorbu odlehčených konstrukcí, které pomáhají snižovat spotřebu paliva a zvyšovat bezpečnost. Ve zdravotnictví se tisknou implantáty a ortopedické náhrady přizpůsobené konkrétní anatomii pacienta, což zvyšuje úspěšnost operací a zkracuje dobu rekonvalescence. tedy

V oblasti vesmírného výzkumu se 3D tisk uplatňuje při výrobě palivových komponent, struktur satelitů nebo náhradních dílů pro mise. Díky této technologii je možné výrazně zefektivnit logistiku i vývoj nových zařízení. V poslední době se aditivní výroba začíná prosazovat i ve stavebnictví. Pomocí velkoformátových tiskáren lze vytvářet betonové konstrukce, celé stěny i domy. Tento způsob výstavby přináší rychlost, úsporu materiálu a nižší ekologickou zátěž. První pilotní projekty dokazují, že dům lze postavit v řádu několika dnů a s minimální spotřebou lidské práce.
Česká republika a její pozice v aditivní výrobě
I v českém průmyslu hraje 3D tisk stále důležitější roli. Mnohé domácí firmy implementují aditivní technologie do svých procesů a začínají je vnímat jako plnohodnotný nástroj pro výrobu, vývoj i servis. Tuzemské vysoké školy a výzkumná centra navíc vytvářejí prostor pro spolupráci s průmyslem, a tím přispívají ke vzniku silného inovačního ekosystému.
Příkladem může být společnost ONE3D, která se zaměřuje na průmyslový 3D tisk plastových dílů technologií SLS. Díky svému know-how pomáhá českým i zahraničním firmám zkracovat dodací lhůty a optimalizovat design výrobků. Společnost Misan zase rozvíjí využití kovového 3D tisku a dodává technologie i služby pro firmy, které potřebují vysoce přesné a odolné komponenty.
Škoda Auto využívá 3D tisk pro výrobu přípravků, držáků a montážních pomůcek. Díky tomu může rychle a efektivně testovat nové komponenty a upravovat výrobní linky. V letectví nachází 3D tisk uplatnění při výrobě optimalizovaných dílů, které splňují náročné požadavky na bezpečnost a životnost.
Velmi aktivní je Česká republika také v oblasti zdravotnických aplikací. Řada firem se specializuje na vývoj a výrobu implantátů, dentálních náhrad nebo ortéz přizpůsobených individuálním potřebám pacientů. Tato řešení jsou často efektivnější, komfortnější a méně invazivní než tradiční metody.

Budoucnost, která se tiskne
Očekává se, že v následujících letech bude význam 3D tisku v České republice dále růst. Aditivní výroba se postupně přesouvá z doplňkového nástroje do role strategické výrobní technologie. Zejména v oblastech s vysokou přidanou hodnotou, jako je letectví, medicína nebo specializované strojírenství, se bude stát nedílnou součástí vývoje a produkce. Důležitým prvkem zůstává i podpora spolupráce mezi výzkumem a průmyslem, stejně jako investice do vzdělávání a rozvoje technických dovedností.
Aditivní výroba již není pouze trendem nebo zajímavostí. Stává se nezbytnou součástí moderního průmyslu. Využívá digitální data, zkracuje vývojové cykly, šetří materiál i energii a umožňuje vznik výrobků, které byly ještě před několika lety považovány za nemožné.



































Ještě před několika lety byl 3D tisk v domácím prostředí doménou technologických nadšenců a kutilů. Dnes se stává běžnou součástí mnoha domácností, kde plní praktickou, kreativní i zábavní roli. Rychlý technologický pokrok zpřístupnil 3D tiskárny široké veřejnosti, a to nejen z hlediska ceny, ale také jednoduchosti ovládání, bezpečnosti a dostupnosti tiskových materiálů.
Zatímco v průmyslu se aditivní výroba využívá především pro optimalizaci výrobních procesů a vývoj nových produktů, v domácnostech slouží 3D tisk jako nástroj pro řešení každodenních potřeb. Uživatelé si tisknou náhradní díly, kuchyňské doplňky, hračky pro děti, vzdělávací pomůcky nebo dekorace. A to vše na základě vlastního návrhu nebo z obsáhlých online knihoven s tisíci bezplatnými modely.

www.epogm.com
Největší sklad komponentů pohonů v ČR
Pohony na míru zákazníkovi
Kompletní řešení pro:
• železniční sektor
• těžký průmysl
• potravinářství
• ATEX provedení
Lineární aktuátory
Servis elektromotorů, převodovek a pohonných komponentů






Dostupnost technologií a materiálů


















Nejčastěji používanou technologií v domácím prostředí je metoda FDM, tedy tisk z plastového vlákna nanášeného vrstvu po vrstvě. Tato tiskárna se dá pořídit už za několik tisíc korun a její provoz je relativně levný. Využívají se především materiály jako PLA, který je biologicky odbouratelný, bez zápachu a vhodný i do interiéru. Pokročilejší uživatelé experimentují i s PETG nebo TPU, tedy flexibilními a mechanicky odolnějšími materiály.
Oblíbené jsou i tiskárny s pryskyřicí, které fungují na principu vytvrzování tekutého materiálu pomocí světla. Tyto modely dokážou tisknout s vysokým rozlišením a hodí se zejména pro výrobu malých detailních předmětů, jako jsou miniatury, šperky nebo přesné mechanické součástky. Jejich obsluha je však náročnější a vyžaduje více péče při práci s chemikáliemi.

Kreativita, udržitelnost i osobní přístup
3D tisk v domácnosti podporuje kreativitu a samostatnost. Z běžných uživatelů se stávají designéři, kteří si mohou upravit každý model přesně podle vlastních potřeb. Není nutné kupovat novou součástku, pokud lze vytisknout přesnou repliku ulomeného plastového držáku nebo ztraceného víčka. Tím se prodlužuje životnost výrobků, snižuje objem odpadu a šetří peníze.
Mnoho domácích uživatelů tiskne také dárky na míru – od personalizovaných figurek až po funkční věci jako stojánky, držáky na telefon, organizéry, vánoční ozdoby nebo deskové hry. Tento přístup dává předmětům osobní hodnotu a přináší radost nejen tvůrcům, ale i obdarovaným.
Ve vzdělávání slouží 3D tisk jako interaktivní pomůcka pro děti i dospělé. Mnohé školy už dnes využívají 3D tisk ve výuce techniky, matematiky nebo výtvarné výchovy. Doma si děti mohou vytisknout vlastní kostky, písmenka nebo mechanické modely, které jim pomáhají lépe pochopit prostorové vnímání a principy fyziky.

CERTIFIKOVÁNO
BEZPEČNOST



Skutečné příběhy domácího využití

Uživatelé napříč světem sdílejí originální a někdy i překvapivá využití domácí 3D tiskárny. Například rodina z jižních Čech si vytiskla náhradní součástky do kuchyňského robotu, které už nebyly dostupné v obchodech. Jiný nadšenec si navrhl vlastní montážní systém pro zahradní zavlažování. Děti často tisknou figurky z oblíbených her, stavebnice nebo vlastní návrhy autíček. Někteří domácí uživatelé vytvářejí složité modely vláčků, letadel nebo historických budov, které by jinak byly velmi drahé.
Perličkou jsou také ti, kteří pomocí 3D tisku rekonstruují části starých spotřebičů, tisknou si nábytek pro panenky, vlastní razítka, obaly na elektroniku, nebo dokonce součástky na domácí meteostanici.
Co je potřeba pro úspěšný začátek
Začít s 3D tiskem dnes není složité. Kromě samotné tiskárny je potřeba i tzv. slicer. Jedná
se o program, který připraví model pro tisk a rozdělí ho na vrstvy. Mezi nejoblíbenější patří Cura nebo PrusaSlicer. Mnoho výrobců tiskáren dodává software přímo s přístrojem a poskytuje podporu v češtině. Dále je třeba mít databázi 3D modelů – tou může být například Thingiverse, Printables nebo MyMiniFactory.
Důležitou roli hraje také základní znalost údržby a bezpečnosti. Tiskárna by měla být umístěna v dobře větraném prostoru a při tisku z pryskyřice je vhodné používat ochranné rukavice a brýle. U plastových filamentů zase pomáhá udržovat konstantní teplotu prostředí, aby nedocházelo k deformacím.
Budoucnost domácího tisku
Vývoj jde dál i v oblasti domácích 3D tiskáren. Přibývají multifunkční zařízení, která kombinují tisk s gravírováním nebo frézováním. Materiály se zdokonalují, přibývají recyklovatelné a plně biologicky odbouratelné filamenty. 3D tiskárna se postupně stává standardní výbavou domácnosti podobně jako počítač nebo mikrovlnná trouba.
S tím, jak roste počet uživatelů, se rozvíjí i komunity kolem 3D tisku. Na sociálních sítích, YouTube nebo v diskusních fórech si lidé vyměňují rady, modely a zkušenosti. Vznikají také lokální sdílené dílny, kde si může tisk vyzkoušet i ten, kdo si zatím netroufá investovat do vlastní tiskárny.






















Kontakt na nás:
Moulds and Tools Technic s.r.o. Hrachovec 288
Valašské Meziříčí 757 01
Ing Jaromír Korábečný +420602555735 j.korabecny @mtt.cz
Pavel Maceček +420 602 789 313 p.macecek@mtt.cz










7 – 10/ 10/ 2025
Novinky více než 1300 českých a zahraničních firem. Technologie, silný program a networking
Den energetiky
setkání lídrů pod hlavičkou Svazu energetiky
Digitální továrna 2.0
digitalizace v praxi, digi stage plná odborných diskuzí a case studies
ROBOTY 2025
robotická expozice, live podcasty, MSV Tour ze světa robotiky
Konference, odborné semináře, B2B setkání
DEFENCEO, Innovative Logistics, schůzky Kontakt-Kontrakt a další
Nákup vstupenek on-line


















Finanční řízení výrobních fi rem se v posledních letech posunulo od tradičního účetnictví a rozpočtování k mnohem komplexnějším procesům. Současný průmysl vyžaduje kombinaci investic do nových technologií, chytré využívání dotací, propracované daňové plánování a zároveň důraz na audity a řízení podnikových rizik. V českém prostředí nacházíme řadu inspirativních příkladů, které ukazují, jak tyto přístupy přispívají k dlouhodobé stabilitě i růstu podniků.
Investice do nových technologií
Bez pravidelné obnovy výrobních linek a zavádění digitálních technologií se dnes žádný podnik neobejde. Největší český výrobce automobilů, Škoda Auto, investuje každoročně 15 až 20 miliard korun do vývoje, výroby a digitalizace. Tyto prostředky směřují nejen do modernizace linek, ale také do robotizace, elektromobility a výzkumu nových materiálů. Podobně Siemens Česká republika investoval už přes 3 miliardy korun do svých závodů v Ostravě a Frenštátě, kde zavádí prvky Průmyslu 4.0 a chytré monitorování výroby.



Právě tyto investice ukazují, že moderní
technologie nejsou jen otázkou prestiže. Umožňují snížit provozní náklady, zvýšit efektivitu a zajistit stabilní zakázkovou náplň. Firmy, které investují do digitalizace výroby a chytrých systémů řízení, získávají významnou výhodu i v boji s nedostatkem pracovníků, protože dokážou udržet výkon s menším počtem zaměstnanců.
Daňová optimalizace a dotační programy

České podniky stále častěji kombinují vlastní zdroje s podporou z veřejných fondů. Operační program Technologie a aplikace pro konkurenceschopnost (OP TAK) disponuje pro období 2021–2027 rozpočtem 80 miliard korun Podpora směřuje zejména na digitalizaci, energetické úspory, obnovitelné zdroje a modernizaci výroby.
Daňová optimalizace pak umožňuje efektivně využít investiční odpočty nebo odpočty na výzkum a vývoj. Jen v roce 2023 tuto možnost využilo více než 1200 českých firem, což jim přineslo miliardové úspory, které mohly zpětně vložit do modernizace. Typickým příkladem je strojírenská firma, která díky investičnímu odpočtu při koupi nových CNC strojů snížila svou daňovou zátěž a současně zkrátila výrobní cyklus až o třetinu.
Finanční audity a interní kontrola
Pravidelné finanční audity se staly nedílnou součástí řízení průmyslových podniků. Nejde jen o naplnění legislativních povinností, ale i o posílení důvěry investorů a bank. Interní audity procesů mají přímý dopad na efektivitu. Podle dat Svazu průmyslu a dopravy ČR je více než 70 % podniků provádí pravidelně, přičemž průměrná úspora dosahuje 5 až 10 % provozních nákladů ročně.
U středně velkých firem to mohou být miliony korun, které lze znovu investovat do rozvoje.




Jeden z příkladů představuje výrobce z oblasti plastů, který díky internímu auditu dokázal odhalit plýtvání energií v sušírnách granulátu a ušetřil ročně přes 12 milionů korun.
Audity inovací a investic zase pomáhají posoudit návratnost projektů. Pokud firma plánuje pořízení nové výrobní technologie, systematická kontrola umožní zhodnotit nejen pořizovací cenu, ale i dlouhodobé náklady na provoz a servis.
Řízení podnikových rizik
Český průmysl je vystaven celé řadě rizik – od výkyvů cen energií přes problémy v dodavatelských řetězcích až po geopolitickou nejistotu. Firmy v energeticky náročných odvětvích, jako je hutnictví, sklářství nebo chemický průmysl, proto čím dál více využívají zajišťovací nástroje. V roce 2022 se průměrná cena elektřiny na spotovém trhu zvýšila meziročně o více než 60 %. Podniky, které neměly ceny energií zajištěné, se ocitly pod tlakem, zatímco zajištěné společnosti dokázaly udržet výrobu bez zásadních výpadků. Řízení rizik se proto stalo integrální součástí finanční strategie firem.
Příklad České exportní banky
Silným partnerem českého průmyslu je Česká exportní banka (ČEB). Ta se specializuje na financování exportu velkých technologických celků a investičních celků, kde je potřeba státní garance. ČEB například financovala vývoz

lokomotiv Škoda Transportation do Turecka a Ázerbájdžánu v hodnotě přes 4 miliardy Kč. V oblasti energetiky se banka podílela na projektech českých dodavatelů pro elektrárny ve Vietnamu a Srbsku, kde se objem financování pohyboval ve stovkách milionů eur. Všechny transakce probíhaly v úzké spolupráci s Exportní garanční a pojišťovací společností (EGAP), která zajišťovala pojištění proti teritoriálním i komerčním rizikům.
FAKTA A ČÍSLA Z FINANČNÍHO ŘÍZENÍ ČESKÉHO PRŮMYSLU
Škoda Auto: 15–20 miliard Kč ročně do vývoje, výroby a digitalizace
Siemens ČR: investice přes 3 miliardy Kč do závodů v Ostravě a Frenštátě
Operační program TAK (MPO): 80 miliard Kč pro období 2021–2027 na podporu inovací a digitalizace
Daňové odpočty na výzkum a vývoj: využívá přibližně 1200 firem ročně
Interní audity procesů: úspory 5–10 % nákladů, potvrzuje Svaz průmyslu a dopravy ČR
Energetické náklady: v roce 2022 růst cen elektřiny o více než 60 % (data ERÚ a OTE)
ČEB: exportní financování projektů v Turecku, Ázerbájdžánu, Vietnamu a Srbsku v hodnotě miliard Kč a stovek milionů eur
















Domažlická 1256/1 Praha 130 00 tel./fax +420 515 536 651 mobil: +420 725 825 594 , +420 725 859 366 obchod@deltatechnologie.cz www.deltatechnologie.cz

















































I NA SLOŽITÉ TRHY

DODÁVÁ S POJIŠTĚNÍM EGAP



AUTOR: JAN ČERNÝ, TISKOVÝ MLUVČÍ EGAP



















Každý den vyrobí Česká zbrojovka v Uherském Brodě kolem dvou tisíc zbraní. Část z nich směřuje přímo na frontu na Ukrajině, další do výzbroje armád a policejních složek po celém světě.. „To, že někam dodáte zboží, je skvělé, ale je potřeba za něj dostat zaplaceno. Pojištění je nedílnou součástí ceny výrobku,“ říká Petr Kallus, ředitel obchodu pro Afriku společnosti Česká zbrojovka, která je součástí Colt CZ Group. Při exportu na náročné trhy se slavná zbrojovka proto spoléhá na exportní pojišťovnu EGAP.


Ročně podnik vyrobí přibližně 400 tisíc kusů zbraní. Přibližně 60 % tvoří pistole, zbytek pak pušky, kulovnice či malorážky.



Na komerčním
trhu převažují hobby střelci, kteří tráví čas na střelnicích a pistole intenzivně opotřebovávají. U myslivců je spotřeba menší, více investují do příslušenství. Česká zbrojovka je ale také dodavatelem pro ozbrojené složky – a to nejen v ČR, kde je hrdým a dlouholetým parterem Armády ČR a Policie ČR. Zbraně z Uherského
Brodu používají ozbrojené složky v desítkách zemí po celém světě – bulharská policie, rumunské četnictvo, francouzské státní četnictvo a jeho elitní protiteroristická jednotka GIGN, maďarská armáda, finská policie, thajské ministerstvo vnitra, brazilská vojenská policie či egyptská policie.
Náročné podmínky panují zejména na afrických trzích, kde je bez pojištění prakticky nemožné obchodovat. „Do některých obchodů se můžeme pustit právě díky pomoci EGAP. Některé obchodní případy by bez spolupráce s pojišťovnou nebyly proveditelné, protože podmínky na africkém trhu jsou velmi specifické,“ vysvětluje Kallus.
Africké země čelí hrozbám terorismu a slabé kontrole hranic. „My si v Evropě těžko představíme, jakému nebezpečí jsou některé státy vystaveny. EGAP nám umožňuje vstoupit na tyto trhy s jistotou,“ dodává.
Jedním z nejviditelnějších příkladů je právě Egypt, kde zbrojovka dlouhodobě dodává pistole tamní policii. Těch je přes 100 tisíc kusů a egyptští policisté je využívají i k ochraně českých turistů. „Bez EGAP bychom takový kontrakt realizovali jen stěží. Díky pojištění jsme schopni odbourat rizika a zároveň poskytnout zákazníkovi jistotu,“ říká Kallus.

i limitované edice – například Řád bílého lva, sérii Anthropoid či CZ 75 RAF, vzdávající hold československým letcům RAF. O tyto kusy je obrovský zájem a často se draží v aukcích.
Významným odbytištěm je v posledních letech také Ukrajina. Do tamních ozbrojených sil proudí zejména bojové pušky CZ BREN 2 ráže 5,56×45 NATO. „Dodávky pro Ukrajinu jsou pro nás prioritní. Chceme pomáhat ve spolupráci s Ministerstvem obrany ČR a dalšími partnery,“ doplňuje Kallus.
Mezi nejslavnější výrobky patří pistole CZ 75, která letos slaví 50 let od uvedení na trh a prodalo se jí přes milion kusů. Dodnes patří mezi nejkopírovanější zbraně světa, po boku legendárního Coltu 1911. Zbrojovka pravidelně uvádí
Nové možnosti
Vloni koupila mateřská skupina Colt CZ českého výrobce nábojů Sellier & Bellot, takže teď, jak se říká, má Colt CZ Group nabito. Akvizice přinesla synergie mezi vývojem a výrobou střeliva a ručních palných zbraní a otevřela dveře na dalších trzích.
Dobrou zprávou nejen pro Colt, ale pro všechny české firmy v odvětví defense je, že pojišťovna EGAP letos spustila Programu podpory obranného průmyslu. Novinka má pomoct tuzemským zbrojařským firmám získat financování potřebné k budování výrobních kapacit v Česku.




S p o l e č n o s t C O R A L s . r . o . n a b í z í c e n o v ě d o s t u p n á

ř e š e n í p r o m o n i t o r o v á n í , ř í z e n í a a n a l ý z u
e n e r g e t i c k ý c h s y s t é m ů , k t e r á j s o u u r č e n a
p r o š i r o k é s p e k t r u m z á k a z n í k ů s e z a m ě ř e n í m
n a s n í ž e n í n á k l a d ů n a e n e r g i i .
Naše platforma s webovými aplikacemi umožňuje:

Sběr a archivaci dat z měřičů a PLC
Šifrovaný přenos dat do webových portálů
Online vizualizaci signálů a alarmů
Analýzu spotřeb a provozních dat
Správu tisíců měřicích bodů
Integraci s existujícími technologiemi


Modulární architektura umožňuje lokální provoz nebo kombinaci s Cloud portálem. Bezpečnost dat je prioritou, komunikace je šifrovaná, s možností redundantního uložení.

Uživatelé mají plnou kontrolu nad energetikou prostřednictvím webového prohlížeče, včetně alarmového systému a automatického reportingu. Řešení firmy CORAL zpracovává více než 800 000 technologických signálů v 800 objektech po celé ČR.



DOPADY NA ČESKÝ PRŮMYSL




Evropská unie připravuje nový víceletý finanční rámec (MFF) na období 2028–2034. Navržený rozpočet o objemu téměř dvou bilionů eur, což odpovídá přibližně 1,26 procenta HDP EU, má reagovat na nové geopolitické a hospodářské výzvy. Zásadní je nejen jeho celkový objem, ale také proměna struktury, která byla výrazně zjednodušena. Zatímco stávající rámec obsahuje šest kapitol, nový návrh počítá pouze se třemi hlavními pilíři. Tento krok má zajistit větší flexibilitu a umožnit přesnější zaměření na aktuální priority, mezi něž patří obrana, bezpečnost, digitalizace, bioekonomika nebo podpora vesmírného výzkumu. Tradiční oblasti, jako je zemědělství a rybolov, se posouvají do pozadí a jsou nově propojeny s politikou soudržnosti.
Rozpočet integruje také program Next Generation EU, který byl původně navržen jako mimořádný nástroj po pandemii. Tím se mění pohled na celkový objem prostředků. Z původního bilionu eur se v předchozích letech navýšily výdaje o dalších 750 miliard prostřednictvím tohoto programu.
Nyní se tato částka stává součástí hlavního rámce a rozpočet tak dosahuje téměř dvou bilionů eur. To však neznamená, že jde o výrazné navýšení proti minulosti, spíše o formální začlenění dosavadních nástrojů do nové struktury.
׀ NOVÉ NÁSTROJE A PRIORITY
Jedním z hlavních prvků navrhovaného rozpočtu je Evropský fond konkurenceschopnosti, který má financovat strategické projekty v oblastech čisté energetiky, digitální transformace, zdravotnictví, biotechnologií a obrany. Dále je navržen mechanismus připravenosti na krize s kapacitou až 400 miliard eur, určený pro mimořádné situace v energetice, zemědělství, civilní ochraně nebo bezpečnosti dodavatelských řetězců. Do rozpočtu je začleněna také dlouhodobá podpora Ukrajiny s alokací až 100 miliard eur na obnovu a postupnou integraci do evropských struktur.
Financování má být zajištěno nejen prostřednictvím příspěvků členských států, ale i pomocí nových vlastních zdrojů. Ty zahrnují výnosy z obchodování s emisními povolenkami, příjmy z uhlíkového cla CBAM, daň z elektronického odpadu, spotřební daň z tabáku či daň z obratu velkých firem s obratem nad 100 milionů eur. Tyto zdroje mají přinášet do rozpočtu desítky miliard eur ročně. Přesto jejich podíl zůstává v poměru k celkovému objemu relativně malý a v rozpočtu budou nadále dominovat příspěvky členských
států. Evropská komise také počítá s využíváním půjček na finančních trzích, zejména pro splácení závazků spojených s pandemií.
׀ POLITICKÉ NAPĚTÍ
Jednání o víceletém finančním rámci tradičně doprovází silné spory mezi členskými státy. Polsko a některé další země prosazují navýstředků a podporují zavedení nových zdrojů financování. Naopak Německo či Nizozemsko odmítají zvy-

šování svých příspěvků a staví se proti dalšímu společnému zadlužování. Politická vyjednávání proto budou probíhat minimálně v příštích dvou letech a výsledný kompromis se stane odrazem schopnosti jednotlivých států prosadit své zájmy. Česká republika bude muset v této debatě obhájit své priority, zejména v oblasti průmyslových investic, energetiky a digitalizace.
Česká republika si i v příštím programovacím období udrží status čistého příjemce fondů. V současnosti činí čistá pozice přibližně 80 až 90 miliard korun ročně. Do budoucna se očekává mírný pokles na 50 až 60 miliard korun ročně, nicméně i nadále bude ČR z evropského rozpočtu čerpat více, než kolik do něj odvádí. Rozdělování prostředků bude nově více závislé na „sdíleném řízení“, tedy dohodě mezi Komisí, členskými státy, regiony a podnikatelskými svazy. To znamená, že regionální a průmysloví aktéři získají větší vliv na to, kam prostředky směřují. České podniky tak budou muset aktivněji připravovat projekty, které odpovídají evropským prioritám, a zároveň prokazovat jejich konkrétní přínosy.
Pro český průmysl to znamená nové příležitosti, zejména v oblastech, na které bude rozpočet klást důraz. Významně se zvyšuje podpora pro obranný průmysl, kde české firmy patří mezi respektované dodavatele. Rozpočet také vytváří nové možnosti v oblasti digitalizace, automatizace výroby a rozvoje biotechnologií. Podniky, které dokážou spojit své investice s evropskými cíli, mohou čerpat prostředky nejen z národních programů, ale i z centrálně řízených evropských fondů.







Nový rozpočet EU po roce 2028 nebude znamenat pouze objemnější prostředky, ale především změnu přístupu. Důraz se přesouvá k projektům s vysokou přidanou hodnotou a k oblastem, které mají strategický význam pro budoucí konkurenceschopnost Evropy. Český průmysl tak stojí před výzvou aktivně se zapojit do nově definovaných priorit a prokázat schopnost využít finanční prostředky efektivně. Úspěch bude záviset nejen na kvalitě projektů, ale i na schopnosti spolupráce podniků, regionů a státní správy při jejich přípravě a obhajobě v Bruselu.



































Svět energetiky




E.ON A KAUFLAND BUDUJÍ
PÁTEŘNÍ SÍŤ DOBÍJENÍ ELEKTROMOBILŮ V ČESK
V Čáslavi u Kauflandu otevřeli dobíjecí hub s výkonem 300 kW. Nabije osm vozů najednou za 15 minut a je součástí projektu
E.ON a Kauflandu na vybudování 120 hubů na zelenou energii do roku 2027.

Svět stavebnictví




KDYŽ TICHO PROMLUVÍ. BUBNY SE MĚNÍ V CENTRUM PAMĚTI, KULTURY I MODERNÍ VÝSTAVBY
V Praze Bubnech začala stavba Centra paměti a dialogu. Projekt studia ARN a Metrostavu DIZ propojí historické nádraží s moderní architekturou. Do dvou let vzniknou sály, edukační prostory i kavárna.

Svět stavebnictví EFORCE PRAGUE





Svět automatizace ČESKÉ LASERY ZAZÁŘÍ V JAPONSKU: CEITEC VUT A START-UP CACTUX SE PŘEDSTAVÍ NA EXPO 2025
V ÓSACE
Na letošním Bosch Tech Day ve Stuttgartu firma jasně ukázala, že umělá inteligence pro ni není jen módní slovo. Bosch sází na AI napříč celým svým byznysem. Nejen ve vývoji, ale i ve výrobě, produktech a každodenním provozu. Do konce roku 2027 chce do AI investovat přes 2,5 miliardy eur a do roku 2035 plánuje z řešení pro asistované a automatizované řízení získat tržby přes 10 miliard eur.

Svět logistiky




FORMULA: BRONZ MEZI AUTONOMNÍMI VOZY NA HOCKENHEIMRINGU
Tým eForce Prague Formula získal bronz v autonomní kategorii na Formula Student Germany v Hockenheimu a celkově skončil desátý. Úspěch monopostu CTU.25 potvrzuje technické kvality i sílu týmu ČVUT.




LOKOTRAIN SPOUŠTÍ DVĚ
MODERNÍ VÝCVIKOVÁ
CENTRA PRO STROJVEDOUCÍ. SOUČÁSTÍ JSOU I ZÁŽITKOVÉ JÍZDY PRO VEŘEJNOST
Technologická a kurýrní společnost Wolt zahájila v Praze pilotní projekt bezemisního doručování s cílem posílit udržitelnou městskou logistiku. Kurýři mají k dispozici dvacet elektromobilů s vyměnitelnými bateriemi, které umožňují výměnu energie během několika vteřin. Praha se tím stala jedním ze tří evropských měst, kde se testuje nová generace městské přepravy.





Svět digitalizace SIEMENS A BAVORSKÁ STÁTNÍ OPERA VYTVOŘILY DIGITÁLNÍ DVOJČE PRO NÁRODNÍ DIVADLO
V MNICHOVĚ
Siemens a Bavorská státní opera vytvořili digitální dvojče akustiky mnichovského Národního divadla. Simulace umožňuje zkoušet orchestrální sestavy či scénickou výpravu ještě před první zkouškou. Součástí projektu je i aplikace ve smíšené realitě Sound of Science. protokolů.

Svět udržitelnosti NOVÁ DAŇ




Z ELEKTROODPADU: POTŘEBNÝ IMPULS, NEBO EKOLOGICKÝ NESMYSL?
Evropská komise plánuje od roku 2028 zavést daň z elektroodpadu s očekávaným výnosem až 15 miliard eur ročně. Česká republika patří mezi evropské premianty – v roce 2022 dosáhla míry sběru 57 %, což je výrazně nad průměrem EU. Nová daň však může zvýšit ceny pro spotřebitele.





Svět financí VELKÝ ÚSPĚCH PRO ČESKO. TOYOTA ZAČNE V KOLÍNĚ VYRÁBĚT ELEKTROMOBILY I BATERIE
Toyota Motor Europe spustí výrobu bateriového elektromobilu v kolínském závodě TMMCZ. Investice ve výši 680 milionů eur zahrnuje rozšíření areálu, novou lakovnu a svařovnu i montáž baterií. Projekt podpoří vláda částkou 64 milionů eur a přinese 245 nových pracovních míst.

kvalitní instalační kabely

Proč instalační kabely od NKT?
V oblasti nízkonapěťových kabelů se NKT zaměřuje na inovace, bezpečnostní standardy a vysoce kvalitní konstrukci. Získáte prvotřídní instalační kabely, které splňují vaše specifické požadavky, splňují všechny mezinárodní normy a jsou testovány na odolnost.
NKT instal PLUS CYKY
Společnost NKT uvedla na náš trh jako první kabely s barevným odlišením na vnějším plášti. Snadno tak rozlišíte 5 základních provedení:
▪ 3x1,5-J modrý
▪ 3x1,5-O červený
▪ 3x2,5-J zelený
▪ 5x1,5-J fialový
▪ 5x2,5-J žlutý



Výrobní závod ve Slaném
— Zákaznické řešení pro váš provoz
— Spolehlivost a dlouhá životnost
— Největší servisní tým po celé ČR
— Servis po celou dobu životnosti




